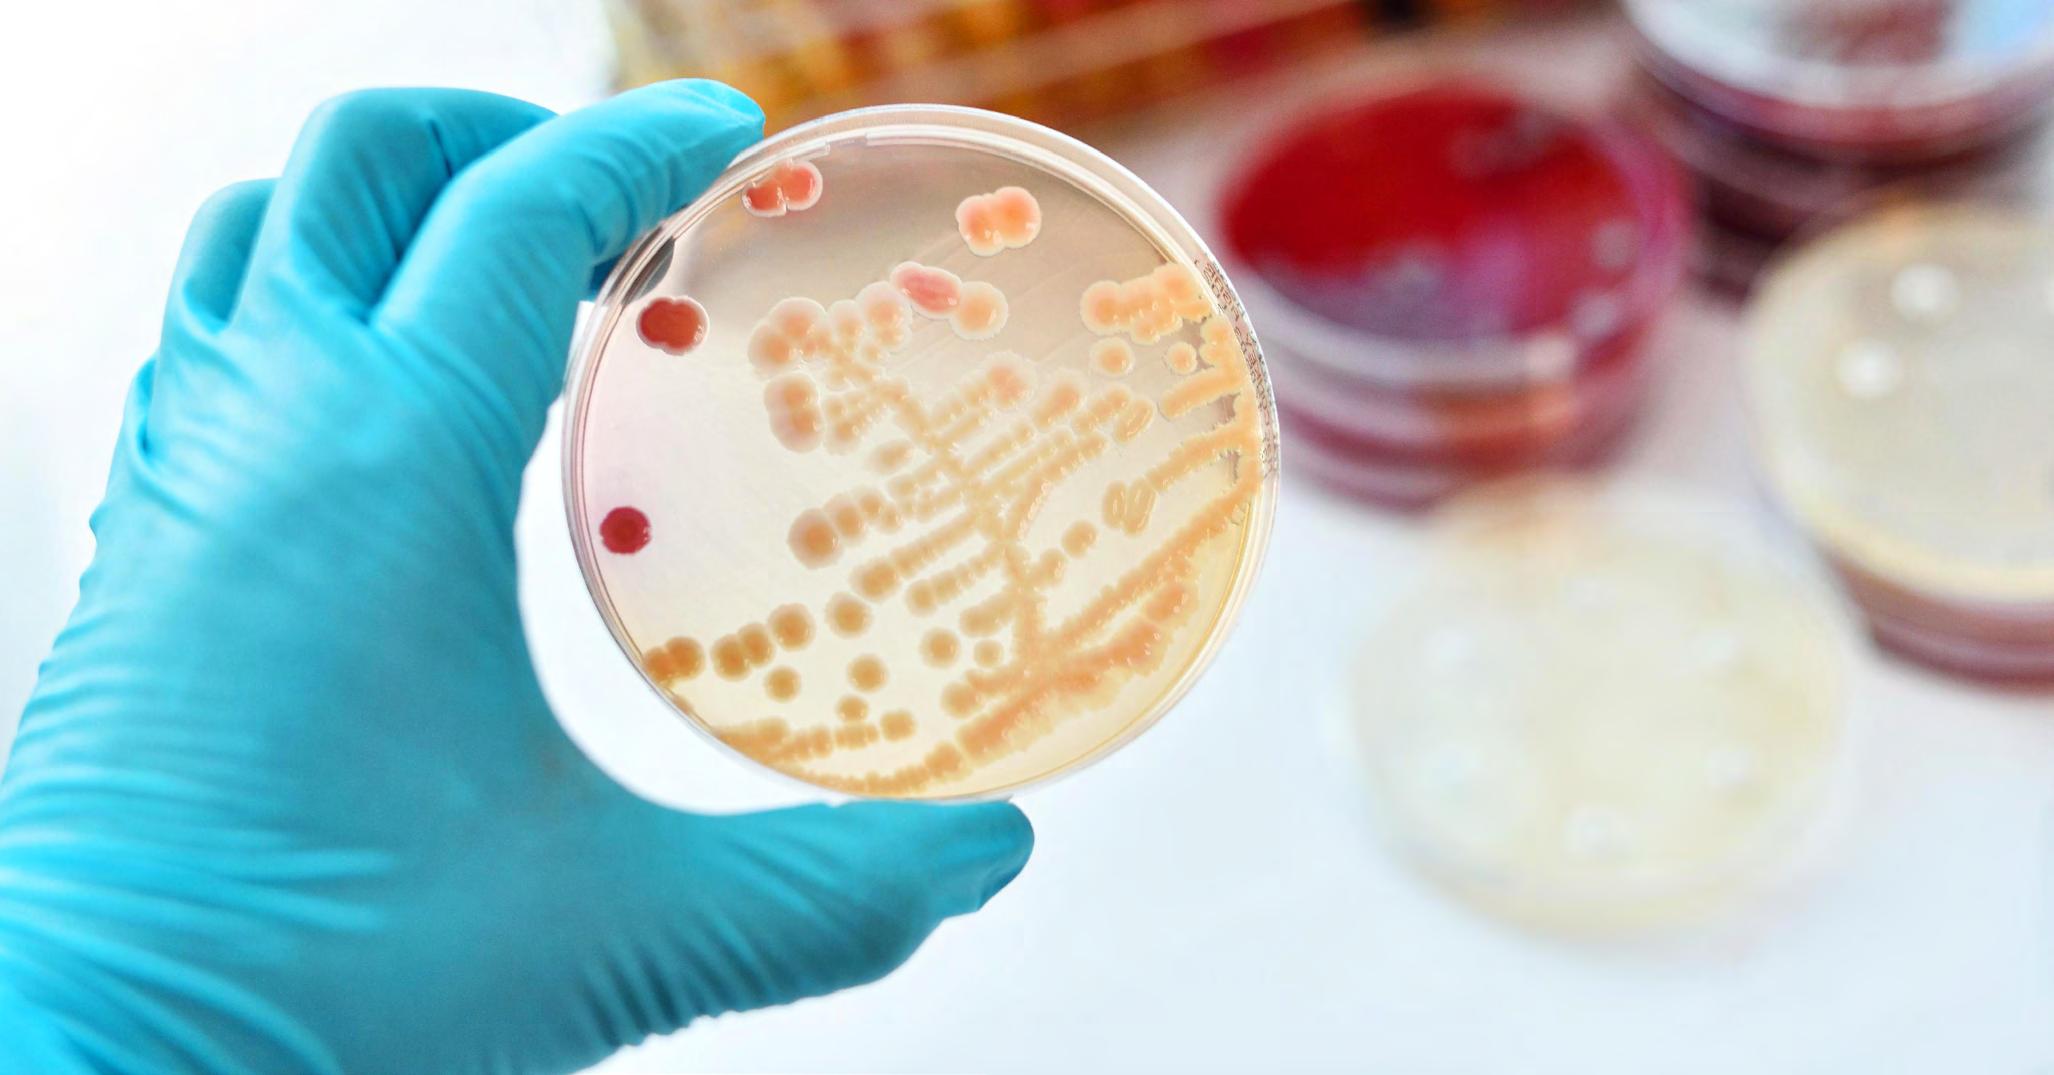

CONSEJO DIRECTIVO consejodirectivo@traductores.org.ar
Presidenta
Trad.a Públ.a Beatriz Rodriguez presidencia@traductores.org.ar
Vicepresidente
Trad. Públ. Norberto Cándido Caputo vicepresidencia@traductores.org.ar
Secretaria general
Trad.a Públ.a Lorena Roqué secretariageneral@traductores.org.ar
Tesorera
Trad.a Públ.a Marisa Viviana Noceti tesoreria@traductores.org.ar
Secretaria de Actas y Matrícula
Trad.a Públ.a Mariana Costa actasymatricula@traductores.org.ar
Vocales suplentes
Trad.a Públ.a María Virginia Rubiolo vrubiolo@traductores.org.ar
Trad.a Públ.a María Verónica Repetti vocalrepetti@traductores.org.ar
TRIBUNAL DE CONDUCTA tribunaldeconducta@traductores.org.ar
Presidente
Trad. Públ. Pablo Andrés Palacios
Vicepresidenta 1.a
Trad.a Públ.a Carina Adriana Barres
Vicepresidente 2.º
Trad. Públ. Marcelo Alejandro Ingratta
Secretaria
Trad.a Públ.a Claudia Elvira Dovenna
Prosecretario
Trad. Públ. Juan Manuel Olivieri
Vocales suplentes
Trad. Públ. Ho Jae Lee
Trad.a Públ.a Ingrid van Muylem
5 Editorial
6 Noticias del Colegio
6 Valores de las legalizaciones
6 Aranceles profesionales orientativos
7 Día del Traductor Público
8 Inscripción de peritos traductores ante el Consejo de la Magistratura de la Ciudad Autónoma de Buenos Aires
9 50.° aniversario del CTPCBA 10
41 Terminología técnico-científica y sus curiosidades: cellulite o cellulitis, por Valeria Marina Bono
42 El español y el lunfardo, por Maximiliano Cuadrado
44 El mundo de la traducción
44 El traductor público, el idioma nacional y la lengua materna: vulnerabilidad y derechos, por Norberto Caputo

16 Noticias del VII Congreso Latinoamericano de Traducción e Interpretación

52 Noticias de la traducción
54 Biblioteca Bartolomé Mitre
55 Librería del Traductor Jorge Luis Borges
Directora: Beatriz Rodriguez
Editor responsable:

Consejo Directivo CTPCBA
Coordinación periodística: Héctor Pavón
Corrección: María Cielo Pipet
Diagramación: Mara Joubert, Laura Kucka y Adriel Peña
La Revista CTPCBA (en línea) es propiedad intelectual del Colegio de Traductores Públicos de la Ciudad de Buenos Aires.

ISSN 2314-1301
Registro de la propiedad intelectual n.º 5059973. El CTPCBA no se hace responsable de las opiniones vertidas en los artículos publicados.

40 Comisiones del Colegio
56 Agenda
58 Juras
59 Capacitación
61 Beneficios
Sumario
Centro
Tribunal
Conducta:
Regional América Latina (CRAL-FIT LatAm) 11
de
Causa N.° 126
siempre en el recuerdo:
Entrevista
Entrevista a Lina Mundet, por Héctor Pavón
Entrevista a Miguel Duro Moreno,
Héctor
26 El pensamiento vivo de los protagonistas del VII Congreso, por Héctor Pavón 34 Concurso Literario Julio Cortázar 35 Traduarte 2023 36 Ryukichi Terao: traducción del japonés al español y del español al japonés, por Stella Maris Acuña
14 Por
adiós a María Kodama y Ángela Hernández 16
a Andrew Gillies, por Héctor Pavón y traducida por Denisse Filippi 20
23
por
Pavón
Revista CTPCBA N.° 157 abril-julio 2023 www.traductores.org.ar 157
Responsable: Ingrid Alejandra van Muylem
Coordinador/a: por designar
Secretario/a: por designar
Integrantes: Rocío Berbel Alt y Juan Manuel Olivieri
Calendario de reuniones: 16/3, 29/6, 27/7, 31/8, 28/9, 26/10, 30/11 y 28/12 a las 18.30
Responsable: María Virginia Rubiolo
Coordinadora: María Alina Gandini Viglino
Secretaria: María Constanza Iglesias Martín
Integrantes: Delfina Aristi, Victoria Barbieri, Bella Rosa Cano, Maximiliano Damián Cuadrado, Eleonora de Pinto, Mónica Esther López de Shinzato, Leticia Ana Martínez, Cecilia Mata, María Celeste Mazzocchi, Lidia Clarisa Pereira González
Aguiar, Ana María Saavedra y Roxana Versace
Calendario de reuniones: 14/3, 9/5, 13/6, 11/7, 8/8, 12/9, 10/10, 14/11 y 12/12 a las 18.30
Responsable: Claudia Dovenna
Coordinadora: Elsa Elisa Predassi Bianchi
Secretaria: Liliana Velasco
Integrantes: Bella Rosa Cano, Yahel Aylen Elias, María
Angélica Grecco Santa Lucía, Alicia Monges, Alicia Margarita
Payo, María Victoria Pinasco, Gilda María Roitman, María Delia
Sors, Lourdes Beatriz Soules y Marina María Villar
Calendario de reuniones: 21/3, 16/5, 27/6, 18/7, 15/8, 19/9, 17/10, 21/11 y 19/12 a las 18.00
Responsable: María Verónica Repetti
Coordinadora: Alicia Damuc
Secretario/a: por designar
Integrantes: María Gimena Alinez, Delfina Aristi, Victoria Barbieri, Graciela Noemí Cademartori, Viviana Raquel Costilla, Silvia Graciela Curchmar, Rosario de Tezanos Pinto, Doelia Gil Flood, Elsa Noemí González Guirado, María Constanza Iglesias Martín, Alicia Laplace, María Magdalena Lombardi, Fabiana Paula Margulis, Ana Oyhamburu, Florencia Verónica Paez Souto, Ana María Saavedra, Mirta Beatriz Saleta, Lucrecia Araceli Tettamanti, Lucía Valerga, Roxana Versace y Teresa Vita Calendario de reuniones: 10/3 a las 17.00
REUNIONES DE LAS COMISIONES INTERNAS DEL CTPCBA
Responsable: Juan Manuel Olivieri
Coordinador/a: por designar
Secretario/a: por designar
Integrantes: Delfina Aristi, Victoria Barbieri, Martín Barrère, Oriela Bruno, Daniela Caballero, Fernanda Lorena Castro, María Victoria Cucchiaro, Eleonora de Pinto, Boris Alan Dufour Frias, Itatí Encinas, Eduardo Sebastián Faure, Martina Constanza González Rodríguez, Iván Iglesias, Verónica Magán Laca, Florencia Verónica Paez Souto, María Cecilia Palluzzi, Teresina Laura Papaleo, María Eugenia Pinalli Sauro, Silvana Rossotto, Alan José Santoro, Lucrecia Araceli Tettamanti, Roxana Venútolo y Daiana Bárbara Zangari Calendario de reuniones: 19/5, 16/6, 18/8, 15/9, 20/10, 17/11 y 15/12 a las 18.00
Responsables: Carina Adriana Barres y Juan Manuel Olivieri
Coordinadora: María Esther Fernández
Secretaria: Alejandra Kachelava
Integrantes: Juliana Noemí Anich Aviani, Delfina Aristi, Mónica Haydée Azcárate, Adriana Bakrokar, Victoria Barbieri, Diana Barreneche, Patricia Úrsula Beauchamp, Rocío Berbel Alt, Claudia Marcela Bertucci, Graciela Noemí Cademartori, Alicia Aurora Carnaval, Clelia Chamatrópulos, Ileana Dall’Aglio, Graciela Darritchon, Marcela Natalia de Laudo, Boris Alan Dufour Frias, Itatí Encinas, Adriana Inés Feregotto, Patricia Frete, Viviana Blanca Gavazza, Déborah Giselle Gelardi, Doelia Gil Flood, Claudia Liliana Goldman, Iván Iglesias, Alicia Laplace, Fabiana Paula Margulis, Carlos Manuel Méndez, Alicia Monges, Silvia Susana Naciff, Carmen Clementina Olivetti, Ana Oyhamburu, Florencia Verónica Paez Souto, Gabriela Silvia Pianzola, Adriana Carla Pilipposian, Esther Elizabeth Poteraica, Diana Patricia Powell, Diana Raimondo, Nora Ana Rodríguez de Bellettieri, Silvana Rossotto, Adriana Gabriela Rubinstein, Ana María Saavedra, Claudia Andrea Sager, Fernanda Salem, Mirta Beatriz Saleta, Alan José Santoro, Sonia Sobek, Inés Storni, Lucrecia Araceli Tettamanti, María Eugenia Torres, Roxana Venútolo, Roxana Versace, Federico Luis Viale y Agostina Zanetto Calendario de reuniones: 14/3, 2/5, 6/6, 4/7, 1/8, 5/9, 3/10, 7/11 y 5/12 a las 18.00
Responsable: Lorena Susana Roqué
Coordinadora: Valeria Marina Bono
Secretario: Federico Luis Viale
Integrantes: Pablo Agustín Aquino, Diana Barreneche, Fernanda Lorena Castro, Cinthia de la Fuente, Valeria Cecilia Esterzon, Silvia Focanti, Vanina Sol Franco, María Alina Gandini Viglino, Iván Iglesias, María Celeste Mazzocchi, Alejandra Cecilia Mierez Revilla, Ana Oyhamburu, Mariano Ezequiel Porto, Carolina Quiroga Rolla, Silvana Rossotto, Emilce Elizabeth Sarlo, Eliana Scasserra, Lucrecia Araceli Tettamanti y Patricia Yurgel Calendario de reuniones: 8/3, 14/6, 12/7, 9/8, 13/9, 11/10, 8/11 y 13/12 a las 18.30
Responsable: Claudia Dovenna
Coordinadora: Estela Lalanne de Servente
Secretaria: Silvia Focanti
Integrantes: María Sol Bellazzi, Silvia Patricia De Santis, María Alina Gandini Viglino, María Gabriela Pérez y Lucrecia Araceli Tettamanti Calendario de reuniones: 7/3, 2/5 6/6, 4/7, 1/8, 5/9, 3/10, 7/11 y 5/12 a las 18.30
Responsables: Carina Adriana Barres y María Virginia Rubiolo
Coordinadora: María Delia Sors
Secretaria: Eliana Scasserra
Integrantes: María Teresa Arias, Gabriela Aspro, Marcia Castro, Susana Fortuna Cohen, Alicia Margarita Payo, María Cecilia Terminiello, Verónica Rita Voegeli y Lidia Wassertheil Calendario de reuniones: 9/3, 4/5, 1/6, 6/7, 3/8, 7/9, 5/10, 2/11 y 7/12 a las 18.30
Responsable: Mariana Costa
Coordinadora: Lucía Mariel Rekofsky
Secretaria: Carolina Veltri
Integrantes: Julieta Baccaro, Agustina Bartocci, Agustina Casarini, María Virginia Conte, Bárbara Vanesa D’Aloi, Andrea Dauria, Martín Emmanuel Fernández, Vanina Sol Franco, María Alina Gandini Viglino, Agustina Camila Gómez, Agustina Gonzalez Dimotta, Silvia Mirta Grossi, María Pía Latorraca, Rocío Mariana Matrero, María José Mc Guire, Carolina Quiroga Rolla, Paula Belén Rodríguez, Adriana Gabriela Rubinstein, Luciana Salusso, Emilce Elizabeth Sarlo, María Sato, Ana Laura Sosa Orrantia y Julia Zarate
Calendario de reuniones: 15/3, 17/5, 21/6, 12/7, 16/8, 20/9, 18/10, 22/11 y 13/12 a las 18.30
Responsable: Norberto Cándido Caputo
Coordinadora: María Sol Bellazzi
Secretaria: Tamara Rey Leyes
Integrantes: Luis Darío Acciardi, María Cecilia Celerier, Clelia Chamatrópulos, Sergio de Paulis, Claudia Dovenna, Adriana Inés Feregotto, Marcelo Alejandro Ingratta, Lidia Irene Jeansalle, Silvia Susana Naciff, Ricardo Naidich, Marisa Viviana Noceti, María Teresa Orlando, Adriana Gabriela Rubinstein, Alan José Santoro, Mariela Débora Sema, Lucrecia Araceli Tettamanti, Micaela Todari, María Eugenia Torres y María Victoria Tuya Calendario de reuniones: 15/3, 17/5, 21/6, 19/7, 16/8, 20/9, 18/10, 15/11 y 20/12 a las 18.30
Responsable: María Virginia Rubiolo
Coordinadora: Julieta López Bárcena
Secretario: Maximiliano Damián Cuadrado
Integrantes: Jorge Rafael Abuchedid, Bella Rosa Cano, Susana Mirta Civitillo, Susana Fortuna Cohen, Marcela Alejandra Cultraro, María Virginia García, María Sol Izquierdo, Rocío Mariana Matrero y María Cecilia Terminiello
Calendario de reuniones: 9/3, 11/5, 8/6, 13/7, 10/8, 14/9, 12/10, 9/9 y 14/12 a las 18.30
Responsable: Marisa Viviana Noceti
Coordinador/a: por designar
Secretario/a: por designar
Integrantes: Patricia Marcela Álvarez, Giuliana Amistadi, María Sol Bellazzi, Norberto Cándido Caputo, Mónica Liliana
Daniele, Sergio De Paulis, Carla Edith Dimarco Calello, Romina Lucía Eloquente, Gabriella Maule, Néstor Puebla Vitale, Juana Rosa Sangiovanni, Marilyn Sheffield y María Agustina Ventura Calendario de reuniones: 1/3, 3/5, 7/6, 5/7, 2/8, 6/9, 4/10, 1/11 y 6/12 a las 18.30
Responsables: Carina Adriana Barres y Pablo Andrés Palacios
Coordinadora: Guadalupe Rivera
Secretario/a: por designar
Integrantes: Marcia Regina Gomes, Adriana Valeria Netto Silva, Diana Patricia Powell, Isabela Pucci, Marcela Patricia Ruiz, Mariana Sánchez y Natalia Vera Gomes Calendario de reuniones: 29/3, 24/5, 28/6, 26/7, 30/8, 27/9, 25/10, 29/11 y 27/12 a las 18.30
Responsable: Norberto Cándido Caputo
Coordinadora: Lidia Irene Jeansalle
Secretaria: Tamara Rey Leyes
Integrantes: Clelia Chamatrópulos, Marisa Viviana Noceti, Carmen Clementina Olivetti, María Teresa Orlando, Néstor Puebla Vitale, María Victoria Tuya y Agostina Zanetto Calendario de reuniones: 28/3, 23/5, 27/6, 25/7, 22/8, 26/9, 24/10, 28/11 y 26/12 a las 18.30
Responsable: Lorena Susana Roqué
Coordinadora: Valeria Cecilia Esterzon
Secretario: Edgardo Adrián Galende
Integrantes: Andrés Basabe, Valeria Marina Bono, Graciela Beatriz Forte, María Alina Gandini Viglino, María Carolina Gutiérrez, Iván Iglesias, Verónica Magán Laca, María Celeste Mazzocchi, Alejandra Cecilia Mierez Revilla, Ana Oyhamburu, Carla Nair Rocca, Alan José Santoro, Emilce Elizabeth Sarlo y Roxana Versace Calendario de reuniones: 1/3, 3/5, 7/6, 5/7, 2/8, 6/9, 4/10 y 1/11 a las 18.30
Responsable: Marisa Viviana Noceti
Coordinadora: Claudia Liliana Goldman
Integrantes: Beatriz Zulema Colman y Silvia Renée Galperín Calendario de reuniones: 9/3, 11/5, 8/6, 13/7, 10/8, 14/9, 12/10, 9/11 y 14/12 a las 15.00
Responsables: Mariana Costa y Lorena Susana Roqué
Responsable: Ho Jae Lee
Coordinador/a: por designar
Secretario/a: por designar
Integrantes: Martín Miguel Cardozo, Clelia Chamatrópulos, Ana María Janku y Leticia Ana Martínez Calendario de reuniones: 30/3, 29/6, 27/7, 31/8, 28/9, 26/10, 30/11 y 28/12 a las 18.30
Responsable: María Verónica Repetti
Coodinadora: Claudia Dovenna
Secretarioria: María Gimena Alinez
Integrantes: Diana Barreneche, María Sol Bellazzi, Nancy Verónica del Tino, Eduardo Sebastián Faure, Luciana Verónica Gómez, Ana Oyhamburu, María Gabriela Pérez, Silvana Rossotto, Sofía Soledad Saposnik, Emilce Elizabeth Sarlo, Cecilia Raquel Silverio y Lucrecia Araceli Tettamanti Calendario de reuniones: 14/3 a las 18.00
Responsable: Marcelo Alejandro Ingratta
Coodinadora: María Sol Bellazzi
Secretaria: Carmen Clementina Olivetti
Integrantes: Rocío Accinelli, Paula Denise Amato, Victoria Barbieri, Diana Barreneche, Oriela Bruno, Ileana Dall’Aglio, Boris Alan Dufour Frias, María Alina Gandini Viglino, Iván Iglesias, Silvia Susana Naciff, Ana Oyhamburu, Silvana Rossotto, Adriana Gabriela Rubinstein, Emilce Elizabeth Sarlo, Lucrecia Araceli Tettamanti y Carla Veniani Calendario de reuniones: 22/2, 8/3, 10/5, 14/6, 12/7, 9/8, 13/9, 11/10, 8/11 y 13/12 a las 18.30
Responsable: Pablo Andrés Palacios
Coordinador/a: por designar
Secretario/a: por designar
Integrantes: Silvia Bacco, Victoria Barbieri, Matías Borich, Clelia Chamatrópulos, Belén Gerez Sanguinetti, Iván Iglesias, María Laura Lemo, Carla Nair Rocca, Alan José Santoro, Lucrecia Araceli Tettamanti y Agostina Zanetto Calendario de reuniones: 31/3, 30/6, 28/7, 25/8, 29/9, 27/10, 24/11 y 29/12 a las 13.30
Responsable: María Verónica Repetti
Coordinadora: Silvia Bacco
Secretario/a: por designar
Integrantes: María Gimena Alinez, Gabriela Aspro, Carina Adriana Barres, Eduardo Sebastián Faure, Lidia Irene Jeansalle, Victoria Alejandra Paniagua, María Cristina Plencovich y Verónica Rafaelli Calendario de reuniones: 8/3 a las 18.00
Coordinadora: Valeria Solange Ques Espinosa
Secretarias: María Sol Izquiero y Marcia Castro
Integrantes: Rocío Accinelli, Agostina Itatí Acosta, Candela Alvarez, Paula Denise Amato, Delfina Aristi, Adriana Bakrokar, Cecilia Barrios, Agustina Bartocci, Andrés Basabe, Rocío Berbel Alt, Melina Sol Bergstreit, Matías Borich, Marcela Buoscio, Natalia Campa, Bella Rosa Cano, Agustina Casarini, Fernanda Lorena Castro, María Virginia Conte, Andrea Dauria, Isabel Julia de Urquiza, Paula Didari, Boris Alan Dufour Frias, Yahel Aylen Elias, Lucía Candelaria Fernández Britos, Vanina Sol Franco, María Alina Gandini Viglino, Belén Gerez Sanguinetti, Luciana Verónica Gómez, Agustina Gonzalez Dimotta, María Carolina Gutiérrez, Iván Iglesias, María Constanza Iglesias Martín, Andrea Laks, María Pía Latorraca, Gisela Leal, María Laura Lemo, Rocío Mariana Matrero, María Celeste Mazzocchi, María José Mc Guire, Gabriela Morisio, Mariano Ezequiel Porto, Isabela Pucci, Paula Belén Rodríguez, Leonel Santángelo Portugal, María Sato, Elena Florencia Sosa Apaza, Lucrecia Araceli Tettamanti, Carla Veniani, María Agustina Ventura, Yessica Lais Wanza, Melina Eleonor Wolaniuk y Julia Zarate
Calendario de reuniones: 29/3, 31/5, 28/6, 26/7, 30/8, 27/9, 25/10, 29/11 y 13/12 a las 18.30

| REVISTA CTPCBA | N.° 157 | ABRIL-JULIO 4
DE FESTEJOS Y MEMORIA
Con orgullo y reconocimiento escribimos estas líneas porque abril nos recibe por la puerta grande.
El 1.º de abril, cuando esta revista salga a la luz, es nuestro día, el Día del Traductor Público, ese ser pleno de recursos y de malabares culturales que a nadie deja a mitad de camino. Y, como si esto fuera poco, el jueves 20 empezará el VII Congreso Latinoamericano de Traducción e Interpretación, que, luego de cuatro apasionantes días, abrirá el almanaque al 50.º aniversario de nuestro querido Colegio.
El mundo, amigos, sigue presa del torbellino de transformaciones y cambios permanentes, y no queda ya tiempo ni para el desconcierto ni para la duda, y menos aún para la improvisación. Mientras se siguen debatiendo la homogeneidad cultural o las fronteras, el gran protagonista de este encuentro, el traductor público, sigue siendo el guardián artesano que dibuja puentes entre distintas y remotas realidades culturales del color que uno ni llega a imaginarse. Sus palabras, esas que unen y comunican, seguirán contribuyendo al acercamiento, confirmando la existencia de una lengua de partida y otra de llegada.
Ya es tiempo de enfrentar a la sociedad con nuevas premisas. El viejo lamento del «desconocimiento social» de nuestra querida profesión debe quedar en el olvido, y debemos autoconvocarnos para poder, desde cada uno de nosotros, hacer un reconocimiento sincero del grado de compromiso que apostamos en cada labor profesional o en la defensa de cada eslabón transitado.
Preservar la identidad cultural es asegurar un lugar en el mundo, que sabemos que tenemos, pues mientras existan seres humanos hará falta comunicarse. Preservar la identidad de objetivos es consolidar nuestro definitivo espacio, que sabemos que hemos adquirido, pero que quizás no hemos aprendido aún a reclamar con suficiente trascendencia.
Con esta premisa y ese espíritu nos reunimos hoy para celebrar con respeto y admiración nuestro día y vivir un microclima de camaradería, profesionalismo y toma de conciencia sostenida y enriquecedora.
Y resulta que el 25 de abril festejaremos los primeros cincuenta años de nuestro Colegio. Ya hablaremos de la historia del Colegio en otro momento, pero él es nuestro como lo son el mate, el tango, las callecitas de Buenos Aires, Piazzolla, Cortázar y tantos ejemplos que vienen a la memoria.
El Colegio ya no es el mismo, hoy es más dinámico, más tecnológico, más abierto a la evolución de los tiempos, los colores y las banderas. Por él caminan, diariamente, cientos de colegas, amigos, público en general; y él, como siempre desde sus inicios, al servicio de todos.
Ahora bien, todos diremos presente en la séptima edición del Congreso Latinoamericano de Traducción e Interpretación y agradecemos, desde ya, toda la energía que cada uno pondrá al servicio de que este congreso sea inolvidable.
Y qué se puede decir del nombre del congreso, en cuanto a que ¡es el séptimo! El primero, que se realizó en 1996, nos convocó, ya sea como asistentes o colaboradores en diferentes tareas. En los cinco posteriores, organizados en 1998, 2001, 2003, 2010 y 2016, se siguió consolidando la idea, ya instalada, de apostar y apuntar al perfeccionamiento continuo, al intercambio entre colegas, al deseo de compartir distintas experiencias bajo un techo común.
Todavía recordamos cuando, en el cierre de la última edición, nos despedimos con la promesa de un próximo congreso latinoamericano. Y, a pesar del tiempo transcurrido, cumpliremos con creces. Para tenerlo, esperamos siete años y pensamos que nada mejor que los festejos del 50.º aniversario del Colegio para que este tuviera un regalo inolvidable, uno de lujo: la posibilidad de albergar en su casa a colegas y estudiantes de diferentes latitudes.
Luego, y por esas cosas que tiene la vida, al CTPCBA también le llegaron «regalos a distancia», y cada invitado, cada orador que convocábamos —lo cual hacíamos, de hecho, con cierta cautela por los tiempos que corren— nos respondía de manera más que solidaria, más que comprometida y sentida.
El 1.º de abril, seremos grandes entre los grandes. Del 20 al 23, nos enriqueceremos el espíritu y el conocimiento, y el 25 brindaremos por eso que es tan nuestro como nosotros mismos: el tan famoso CTPCBA.
Colegas, la invitación a disfrutar está planteada.
Somos los artífices de un mundo mejor, no lo olvidemos jamás.
¡Feliz Día del Traductor Público! ¡Feliz aniversario, Colegio! El Consejo Directivo
5 REVISTA CTPCBA | N.° 157 | ABRIL-JULIO |
Editorial
157
Revista CTPCBA N.° 157 abril-julio 2023 www.traductores.org.ar
Noticias del Colegio
VALORES DE LAS LEGALIZACIONES
A continuación, informamos los valores de las legalizaciones, que rigen desde el 3 de abril de 2023.
LEGALIZACIÓN URGENTE
(Trámite presencial en el acto. Puede presentarse espontáneamente o solicitar turno para una atención prioritaria)
LEGALIZACIÓN SIMPLE
(Trámite presencial diferido. Puede presentarse espontáneamente y estará listo a las 24 horas hábiles)
LEGALIZACIÓN REMOTA/ POR MENSAJERÍA
(Trámite a través del servicio de mensajería con turno. Demora 48 horas hábiles. Disponible en CABA)
LEGALIZACIÓN DE FIRMA DIGITAL
(Demora 48 horas hábiles a partir de la acreditación del pago)
CONSTANCIAS
(Demora 24 horas)
SEDE DE AVDA. CORRIENTES
$ 3000
$ 2900
$ 2900
$ 2800
$ 2900
ARANCELES PROFESIONALES ORIENTATIVOS
Se informa a los colegas que, acompañando los índices inflacionarios registrados en nuestro país, se ha resuelto aplicar un aumento a los valores de los aranceles orientativos de traducción e interpretación y a los de actuación pericial.
El Consejo Directivo recomienda respetar los valores publicados y desalienta la aplicación de aranceles sensiblemente inferiores a los sugeridos por la institución.
El citado aumento entró en vigencia el 3 de abril de 2023 y los nuevos valores se encuentran disponibles para su consulta en el sitio web del Colegio: https://www.traductores.org.ar/ matriculados/aranceles-orientativos/.
Avda. Corrientes 1834. (C1045AAN) CABA | Tel./Fax: 4373-7173 (líneas rotativas)
Recepción e Informes informes@traductores.org.ar
Legalizaciones
Lunes a viernes de 9.00 a 18.00. legalizaciones@traductores.org.ar legalizaciondigital@traductores.org.ar
Pago de la cuota anual
En línea: https://www.traductores.org.ar/ matriculados/cuota-anual/ Consultas: cuotas@traductores.org.ar
ASESORÍAS PARA MATRICULADOS
Asesoría jurídica
Dr. Oscar Pereira asesorialetrada@traductores.org.ar joscarpereira@yahoo.com.ar
Matrícula y Credenciales matricula@traductores.org.ar
Capacitación e inscripción en cursos cursos@traductores.org.ar capacitacion@traductores.org.ar
Biblioteca biblioteca@traductores.org.ar
Librería
libreria@traductores.org.ar Relaciones Institucionales institucionales@traductores.org.ar
Asesoría contable Dra. Liliana Etchetto asesoriacontable@traductores.org.ar asesoriacontablectpcba@gmail.com
Logística y Servicios Generales logistica@traductores.org.ar
Gerencia General gerenciageneral@traductores.org.ar Comité de Solidaridad comitedesolidaridad@traductores.org.ar
SEDE DE AVDA. CALLAO
Avda. Callao 289, 4.° piso. (C1022AAC) CABA Tel./Fax: 4371-8616 • 4372-2961/7961
Capacitación y Eventos cursos2@traductores.org.ar cursos3@traductores.org.ar
Comisiones infocomisiones@traductores.org.ar
Publicaciones y Diseño revista@traductores.org.ar

| REVISTA CTPCBA | N.° 157 | ABRIL-JULIO 6 Novedades institucionales NOTICIAS DEL COLEGIO
Los conceptos y las opiniones expresados por los asesores y colaboradores externos no comprometen la opinión del CTPCBA.

Noticias del Colegio
Inscripción de peritos traductores ante el Consejo de la Magistratura de la Ciudad Autónoma de Buenos Aires
Apartir del 3 de abril y hasta el 21 de abril de 2023 inclusive, se realizará la inscripción de peritos traductores ante el Consejo de la Magistratura de la Ciudad Autónoma de Buenos Aires.
La convocatoria comprende la conformación del Registro de Auxiliares de la Justicia para desempeñarse ante los tribunales dependientes del Poder Judicial de la Ciudad Autónoma de Buenos Aires. La inscripción se realizará en forma virtual, para lo cual deberá descargar el formulario en el siguiente enlace: https://www.traductores.org.ar/wp-content/uploads/ 2023/03/Formulario-Inscripcion-Perito-MagistraturaCABA.pdf y enviarlo completo a legalizaciones2@traductores.org.ar junto con el comprobante de pago del arancel pertinente.
Cabe destacar que, si posee matrícula en más de un idioma, deberá completar tantos formularios como inscripciones posea y abonar la suma correspondiente a esa cantidad de inscripciones.
Requisitos:
— Contar con la cuota 2023 abonada.
— Tener una antigüedad mínima de cinco años en la matrícula. Por lo tanto, solo podrán inscribirse aquellos traductores públicos que hayan prestado juramento antes del 3 de abril de 2018.
— No tener sanciones disciplinarias en el ejercicio de la profesión en los últimos dos años.
— Pagar el arancel de $4000. El pago deberá realizarse mediante transferencia bancaria o depósito a la siguiente cuenta: Banco Santander Río, cuenta corriente n.º 011815/6, sucursal 169, CBU 0720169720000001181568.
— El trámite se completará con el envío del respectivo comprobante de pago por correo electrónico a legalizaciones2@traductores.org.ar junto con el formulario de inscripción completo.
¿Cómo completar el formulario?
A fin de evitar inconvenientes con los datos que ingrese, le solicitamos tener presentes estas recomendaciones:
SOLICITUD N.º Déjelo en blanco
INCUMBENCIA
TÍTULO UNIVERSITARIO
EXPEDIDO POR
FECHA DE EXPEDICIÓN
MATRÍCULA
Complete «TRADUCTOR/A PÚBLICO/A DE IDIOMA ____________»
Ingrese la universidad en la que obtuvo su título, sin abreviaturas
Ingrese la fecha de expedición de su diploma
FECHA DE EXPEDICIÓN Ingrese su fecha de matriculación (puede verificarla en su credencial)
FECHA DE ANTIGÜEDAD DE OTRO CONSEJO Déjelo en blanco
ESPECIALIDAD Déjelo en blanco
| REVISTA CTPCBA | N.° 157 | ABRIL-JULIO 8 Novedades institucionales NOTICIAS DEL COLEGIO

Noticias del Colegio
CENTRO REGIONAL AMÉRICA LATINA (CRAL-FIT LatAm)
América Latina y su propio espacio común
El IV Congreso Latinoamericano de Traducción e Interpretación organizado por el CTPCBA en 2003 fue el esperado y natural ámbito de materialización de un proyecto que, aunque largamente albergado por numerosas entidades y asociaciones profesionales de América Latina, comenzó a tomar cuerpo en agosto de 2002, con ocasión del XVI Congreso Mundial de la Federación Internacional de Traductores (FIT), en la ciudad de Vancouver. En tal oportunidad, los colegas latinoamericanos allí presentes, a propuesta del CTPCBA, se adhirieron al proyecto de formación del Centro Regional América Latina (CRAL), con el objeto de representar a los profesionales de la región, agrupados en distintas entidades, bajo una denominación común y una identidad propia.

Los firmantes de la Declaración de Voluntades fueron los siguientes: Asociación Argentina de Traductores e Intérpretes, Colegio de Traductores Públicos de la Ciudad de Buenos Aires, Universidad Argentina de la Empresa, Asociación Cubana de Traductores e Intérpretes, Organización Mexicana de Traductores, Colegio de Traductores Profesionales del Perú, Colegio de Traductores Públicos del Uruguay, Asociación Guatemalteca de Intérpretes y Traductores.
En el I Congreso Internacional de Traductores e Intérpretes del Perú, adhirieron a la mencionada declaración las siguientes entidades: Universidad Femenina del Sagrado Corazón (Perú), Universidad Ricardo Palma (Perú), Asociación de Traductores Profesionales del Perú, Asociación Gremial de Traductores de Santiago de Chile, Asociación Venezolana de Terminología (VenTerm).
Durante el IV Congreso se sumó a la larga lista de miembros del CRAL la Asociación Bolivariana de Intérpretes y confirmaron su inclusión la Asociación Colombiana de Traductores e Intérpretes y la Universidad Nacional de Costa Rica (Escuela de Literatura y Ciencias del Lenguaje).
Guiadas por la letra y el espíritu de la Declaración de Voluntades, las entidades firmantes, presentes en el IV Congreso, concurrieron a la reunión informativa sobre la constitución formal del Centro Regional, a la que
asistieron numerosos integrantes de otras asociaciones de traductores de América Latina. Durante un fluido intercambio, los participantes expusieron las distintas realidades de los países de procedencia, manifestaron sus inquietudes respecto de la constitución y el funcionamiento del Centro y se comprometieron a plantear la posibilidad de participación ante sus respectivas asociaciones.
Los representantes adherentes a la Declaración de Voluntades llevaron a cabo la reunión para redactar el Acta Fundacional, que se inició el 2 de mayo de 2003 y se reanudó el día siguiente, cuando se constituyó oficialmente el CRAL.
El Comité Ejecutivo del CRAL quedó entonces conformado de la siguiente manera:
Presidencia: ARGENTINA, traductora pública Beatriz Rodriguez, en representación del CTPCBA.
Vicepresidencia 1.ª: CHILE, traductor Hans Grof, en representación de la Asociación Gremial de Traductores de Santiago de Chile.
Vicepresidencia 2.ª: CUBA, traductores Estela Díaz Barbazán y Luis Alberto González Moreno, en representación de la Asociación Cubana de Traductores e Intérpretes.
Secretaría: URUGUAY, traductora pública Mirna Lorente, en representación del Colegio de Traductores Públicos del Uruguay.
Tesorería: PERÚ, traductora Graciela Wachtel, en representación de la Asociación de Traductores Profesionales del Perú.
Con el paso del tiempo, el CRAL devino en el actual FIT LatAm, que ha desarrollado múltiples actividades y ha sabido conservar y darles sostenido empuje a los queridos proyectos que tuvo el CRAL cuando se creó.
El 3 de mayo de este año, el hoy FIT LatAm cumplirá sus primeros veinte años, y una mesa de recuerdo y lindas anécdotas será una de las invitadas especiales de nuestro querido VII Congreso. ¡A no perderse ese momento!
| REVISTA CTPCBA | N.° 157 | ABRIL-JULIO 10
Novedades institucionales NOTICIAS DEL COLEGIO
Causa N.° 126
Buenos Aires, 22 de diciembre de 2022
AUTOS Y VISTOS:
A fs. 2/3 el Traductor Público Néstor Manuel Puebla Vitale (el «Denunciante») interpone denuncia contra la Traductora Pública Beatriz Dominga Merlo (la «Denunciada»), por presunta violación al Código de Ética, que fuera girada a este Tribunal de Conducta por el Consejo Directivo, con fecha 5 de agosto de 2022.
El Denunciante basa su denuncia en que la Denunciada estaría ofreciendo la traducción de documentos personales al idioma italiano a razón de $3500. Manifiesta haber tomado conocimiento de ese extremo por un cliente, quien le preguntó el motivo de la diferencia existente entre los honorarios que él había informado y los que fueran presupuestados por otra traductora (la Denunciada) en un correo que el Denunciante acompaña como prueba (el «e-mail»).
El e-mail posee fecha 18 de julio de 2022 y fue enviado por la Denunciada en respuesta a una consulta del Sr. Daniel Minteguiaga (zoltars2000@gmail.com), quien había preguntado el valor por la traducción de 6 documentos personales al idioma italiano.
En el e-mail puede leerse que la Denunciada informó al Sr. Minteguiaga que el valor por documento era de $3500 y que trabajaba con firma ológrafa.
Ratificada la denuncia por el Denunciante, el 19 de agosto de 2022, este Tribunal resolvió proseguir con la causa y correr traslado a la Denunciada para que ejerza su derecho de defensa, quien debidamente notificada presentó su descargo a fs. 11.
En su descargo, la Denunciada manifiesta preliminarmente no conocer al Denunciante y diagrama su defensa en base a tres puntos concretos. En el primero de ellos, manifiesta no recordar el intercambio con el supuesto cliente, acompañado como prueba por el Denunciante, reconoce la dificultad que posee para el manejo de los medios electrónicos, que atribuye a su edad, y que seguramente existió un error de tipeo y de comunicación, dado que no pudo tener a la vista la documentación por cuya traducción el supuesto cliente le consultó «para poder brindar un presupuesto correcto».
En el segundo punto de su descargo, la Denunciada manifiesta tener muchos años de ejercicio profesional sin
haber tenido nunca una sanción en su contra, habiéndose «ceñido a los valores fijados en los convenios de aranceles». Se manifiesta «tristemente sorprendida» por el hecho de que el Denunciante no se haya comunicado previamente con ella para «aclarar la situación». Declara haber «apostado siempre por valores éticos» y considera que es «una profesional decente».
En tercer y último lugar, expresa que se la está denunciando por una situación que nunca ocurrió en la realidad porque nunca realizó esas traducciones.
A fs. 12, atento la existencia de hechos controvertidos, se abrió a prueba la presente causa, teniéndose presente la documental acompañada por el Denunciante (el e-mail) y dejando constancia de que la Denunciada no ha aportado ninguna prueba con su descargo. Asimismo, como medida para mejor proveer, este Tribunal decidió cursar una consulta al Sector de Legalizaciones de este Colegio de Traductores Públicos de la Ciudad de Buenos Aires («CTPCBA») para que informe: a) el volumen mensual de legalizaciones efectuadas por la TP Beatriz Dominga Merlo y por el TP Néstor Puebla Vitale desde el 1.° de enero de 2022 hasta la fecha del informe y b) si durante el año 2022 existe constancia de una legalización efectuada por la TP Beatriz Dominga Merlo a nombre del Sr. Daniel Minteguiaga.
El Sector de Legalizaciones del CTPCBA respondió la consulta por correo electrónico, cuya impresión se encuentra glosada a fs. 14. De la misma surge que el volumen mensual de legalizaciones del Denunciante resulta superior al de la Denunciada, en el período consultado. Con relación a la existencia de alguna legalización efectuada por la Denunciada a nombre del Sr. Daniel Minteguiaga, la respuesta es negativa.

A fs. 15 se decidió la clausura del sumario en los términos del art. 34, corriendo traslado a la Denunciada para que alegue sobre el mérito de la prueba.
La Denunciada no hizo uso de su derecho a alegar. Vencido el plazo para alegar, el expediente se encuentra en estado de dictar sentencia.
CONSIDERANDO:
Que la única prueba acompañada por el Denunciante no ha sido impugnada, desconocida ni cuestionada por la Denunciada en cuanto a su validez y existencia. Es más,
11 REVISTA CTPCBA | N.° 157 | ABRIL-JULIO | Novedades institucionales NOTICIAS DEL COLEGIO
Noticias del Colegio
la propia Denunciada reconoce tácitamente ese correo, limitándose a mencionar que podría existir un error de tipeo en la suma allí consignada.
Que parecería advertirse en la Denunciada cierta ligereza o falta de cuidado en las consideraciones que pueden ser vertidas en un correo electrónico, cuando pretende, en su defensa, sustentar su cotización en que no pudo ver la documentación involucrada en el e-mail, no efectuando reserva alguna en el texto que envía como cotización. Dicha ligereza o falta de cuidado queda en evidencia al advertir la contundencia de la cotización informada al consultante, dado que, se reitera, no realizó ninguna salvedad al respecto.
Otro argumento que la Denunciada esgrime en su defensa, que no podrá ser considerado como defensa válida, es el hecho de no haber realizado el trabajo cotizado por debajo del arancel mínimo orientativo. Cabe resaltar que su realización dependía del potencial cliente y la cotización dependía de la Denunciante, en quien ha resultado más que clara su intención de cobrar un valor 40 % inferior a los aranceles mínimos orientativos vigentes a la época (julio de 2022). En ese momento, los honorarios mínimos eran de $5280 por la traducción al idioma extranjero de partidas, pasaportes, certificados y demás documentación personal, para ese idioma.
A esta altura, cabe recordar que el criterio sustentado por este Tribunal de Conducta en todas sus resoluciones es el de cumplir los aranceles mínimos orientativos del CTPCBA, ello en virtud del art. 10 del Código de Ética, ordenamiento que todos los matriculados han jurado o prometido cumplir en el acto de matricularse, con independencia de las normas desreguladoras dictadas por el Poder Legislativo o Ejecutivo de la Nación. A mayor abundamiento, el artículo citado dispone que el traductor público «deberá abstenerse de cobrar honorarios que impliquen o estimulen la competencia desleal».
Ofrecer a un potencial cliente realizar un trabajo por un monto 40 % inferior a los aranceles mínimos orientativos es una competencia desleal con el traductor público que cumple las normas del CTPCBA y se rige por dichos aranceles para justipreciar su trabajo.
Merece mención aparte la forma en que la Denunciada se refiere a dichos aranceles, lo que parecería ser un indicio de su falta de consideración, su descuido u omisión
Se recuerda a los matriculados que en el sitio web del CTPCBA (www.traductores.org.ar), en la pestaña «Matriculados», encontrarán la sección «El Tribunal informa», donde verán reflejada la actividad del Tribunal de Conducta y podrán acceder a las sentencias dictadas por ese órgano.
en regirse por ellos, al decir que se ha «ceñido a los valores fijados en los convenios de aranceles». En el caso no existe ningún convenio de aranceles sino que, como ya se mencionara ut supra, se trata de una exigencia contenida en el Código de Ética del colegio profesional en el que la Denunciada se encuentra matriculada.
Por último, las demás consideraciones realizadas por la Denunciada sobre su trayectoria y obrar ético en sus años de ejercicio profesional nada aportan para la solución de esta causa ni este Tribunal tiene por qué dudar sobre dicha aseveración.
En consecuencia, en mérito a lo expuesto, teniendo en consideración la falta de antecedentes disciplinarios de la traductora a quien se le imputa la conducta contraria a los principios éticos enunciados precedentemente, este Tribunal de Conducta RESUELVE, por unanimidad

1) Aplicar a la Traductora Pública Beatriz Dominga Merlo, N.º de Inscripción 1380, la sanción de APERCIBIMIENTO, conforme lo prescripto por el art. 25 inc. a) de la Ley N.º 20.305 y el artículo 10 del Código de Ética. Con costas (artículo 41 de las Normas de Procedimiento).
2) En atención a lo establecido en el apartado anterior, fíjanse las costas del proceso a cargo de la sancionada en la suma de PESOS DOS MIL CIEN ($2100), con más los intereses de tasa activa nominal anual vencida a treinta días que percibe el Banco de la Nación Argentina en sus operaciones ordinarias de descuento, devengados desde los diez días hábiles transcurridos desde la notificación de la presente y hasta su efectivo pago.
3) Notifíquese a la Denunciada y al Denunciante por Secretaría. Comuníquese al Consejo Directivo acompañando copia de la presente decisión. Comuníquese, asimismo, al Sector de Legalizaciones del CTPCBA a fin de efectivizar el cobro de las costas impuestas a la Denunciada. Una vez firme y consentida, publíquese en el órgano de difusión de este Colegio (artículo 38 de las Normas de Procedimiento) y archívese.
FIRMADO: Pablo Palacios, presidente; Carina Barres, vicepresidenta primera; Marcelo Ingratta, vicepresidente segundo; Claudia Dovenna, secretaria.
| REVISTA CTPCBA | N.° 157 | ABRIL-JULIO 12
Novedades institucionales NOTICIAS DEL COLEGIO

Noticias del Colegio
POR SIEMPRE EN EL RECUERDO
Adiós a María Kodama, divulgadora de Borges y amiga del CTPCBA


Con dolor, y también con el cariño que dejan los buenos momentos compartidos, despedimos a María Kodama, la heredera universal del autor de El aleph, custodia de su legado, creadora de la Fundación Internacional Jorge Luis Borges y viuda del gran escritor. A lo largo de los años, mantuvo un cálido vínculo con el Colegio.
El 26 de marzo, a los 86 años de edad, murió María Kodama, escritora, traductora, colaboradora y heredera universal de la obra de Borges, y también su viuda. Deja una profunda huella en su trabajo permanente por la difusión y permanencia de la figura de uno de los mejores escritores de la historia de la literatura universal. El autor de Ficciones había fallecido también a los 86 años, en junio de 1986, en la ciudad suiza de Ginebra, dos meses después de contraer matrimonio con Kodama.
Kodama había nacido el 10 de marzo de 1937 en Buenos Aires, hija del japonés Yosaburo Kodama y de la argentina María Antonia Schweizer, de ascendencia suizo-alemana, inglesa y española. Se graduó como licenciada en Literatura en la Universidad de Buenos Aires y se especializó en literatura sajona e islandesa, de la que hizo traducciones al español. Kodama tomó contacto con la obra de Jorge Luis Borges cuando era una niña. A los 7 años, una profesora de Inglés le leyó los «Two English Poems» del escritor.
Un año después, leyó en una revista el comienzo del cuento «Las ruinas circulares». Y a los 12, la llevaron a una conferencia que daba Borges. Cuando tenía 16, y él 54, se chocó con Borges en la calle, a la salida de una librería. Ella le contó que iba a estudiar Literatura y él la invitó a estudiar juntos inglés antiguo. Nunca más se separaron. Con el tiempo, de discípula, se convirtió en compañera y amiga de Borges y, finalmente, en su esposa.
Kodama mantuvo un cálido vínculo con nuestro Colegio. Participó de actividades y cedió el nombre del más grande escritor argentino para dárselo a la Librería del CTPCBA. Fue exactamente el 14 de agosto de 2009, día en que comenzó a funcionar la Librería del Traductor Jorge Luis Borges. El nombre surgió de una votación realizada entre los matriculados. Aquel día, y como marca permanente del evento, se descubrió la placa que le da ilustre nombre a la Librería.
Un mes antes, Kodama había participado del II Foro Internacional sobre
Traducción Especializada: «Borges, entre el escritor y el traductor», encuentro en el que se destacó como invitada de honor. En aquella ocasión fue entrevistada por la Revista CTPCBA. Reproducimos un extracto de aquel diálogo:

Borges decía que el buen traductor podía mejorar, incluso, el original...
Sí, y es verdad. La traducción es como la música del que compone, es decir, es una tarea muy difícil, porque hay que entrar prácticamente en la psicología del autor, empaparse de los
| REVISTA CTPCBA | N.° 157 | ABRIL-JULIO 14 Novedades institucionales NOTICIAS DEL COLEGIO
términos, de la forma de sentir, de los giros en la lengua original de ese autor, y luego hacer la transmutación de todo eso a la propia lengua. Y si el traductor tiene un profundo conocimiento de su propia lengua, a veces, puede mejorar un texto que no es excelente...
¿Borges tenía diálogo con algún traductor?
Él era amigo de Emilio Stevanovich, un famoso intérprete, con quien hablaba de traducción. También tenía relación con Rolando Costa Picazo, que es realmente un gran traductor. Como decía Borges: un militante de la traducción.
En abril de 2022, para el cumpleaños número 49 del Colegio, tuvimos el honor de contar nuevamente con la presencia de María Kodama, quien
se mostró muy animada y contenta de participar en el festejo.
Casi sobre el final del acto, la traductora pública Beatriz Rodriguez, presidenta del CTPCBA, le agradeció a Kodama por haber permitido que se bautizara con el nombre de Borges la Librería del Colegio, que ya llevaba trece años de trabajo firme y fecundo. Entonces, Kodama dirigió unas palabras a los presentes: «Agradezco la invitación, el apoyo. Un traductor y el autor de una obra son como el trabajo conjunto, la cotarea que realizan un actor y el autor del texto teatral: se entra en el pensamiento del que escribió, uno debe interiorizarse y ser el actor y el autor. Mostrar el mensaje de ese personaje, ese es el trato. Se deja ser uno para ser el otro».


Luego, Kodama contó cómo conoció a Borges: «Yo tenía 16 años y él me preguntó qué iba a estudiar y, cuando le dije que quería aprender lengua anglosajona antigua, me propuso estudiar juntos. Después, mi padre me autorizó, remarcándome: “No haga nada que perjudique su futuro”».
La celebración tuvo un broche de oro con la visita de Kodama a la Librería renovada en la planta baja de la sede de Avda. Corrientes del
Despedimos a la colega Ángela Hernández

| Por la traductora pública Marisa Noceti
Con gran pesar, supimos del fallecimiento de la colega Ángela Hernández, traductora pública tanto de italiano como de inglés.
Tuve el honor de compartir con ella muchos años en la Universidad de Buenos Aires, donde fue coordinadora de italiano y directora de la carrera.
Fue una persona avanzada en el tiempo, dedicada con pasión a todo lo que emprendía, y se adelantaba con acierto a todo aquello que podía
beneficiar a la profesión y la carrera en sí misma.
Fue una precursora con el laboratorio de idiomas en la Universidad y estuvo siempre dispuesta a avanzar y a colaborar con el colega y el alumnado.
En 2018 se celebraron los cincuenta años del traspaso de la carrera de Traductor Público de la Facultad de Ciencias Económicas a la Facultad de Derecho, y tuvo su justo reconocimiento.
Colegio. Allí, la viuda del autor de El aleph recorrió los estantes, apreció los volúmenes de Borges y sus traducciones, y compartió un momento de fructífera charla con la presidenta del CTPCBA y todos los que se acercaron allí para vivir el gran cierre de la fiesta de cumpleaños del Colegio.
Saludó a todos con afecto, miró la placa con el nombre de la Librería por última vez y partió.
«La mejor enseñanza que me ha dejado Borges es disfrutar de la vida, que la vida es maravillosa. Viajábamos mucho, estudiábamos muchos idiomas... Todo era muy divertido, nos lo pasábamos muy bien. La vida era un juego con él», había dicho Kodama a la agencia de noticias EFE en 2015.
Seguramente, muchos colegas la recordarán en sus clases de Régimen Legal de la Traducción y del Traductor Público, donde instaló su impronta personal. Fue un gusto pasar con ella tantos años de docencia y de recorrido compartido.
¡Gracias, Angie, por tantos buenos momentos!
15 REVISTA CTPCBA | N.° 157 | ABRIL-JULIO |
Ángela Hernández
Andrew Gillies:
«La toma de notas es una expresión de nuestro análisis del discurso de origen»
El reconocido intérprete de conferencias Andrew Gillies adelanta en esta entrevista el tema que abordará en el VII Congreso, en abril. Se referirá al lugar decisivo que ocupan las notas en la página para una interpretación consecutiva. Analiza en profundidad las distintas formas de tomar notas en el momento de interpretar, algo clave para un buen desempeño profesional.

Se suele decir que la interpretación consecutiva no se puede aprender y que la toma de notas depende de la personalidad del intérprete. ¿Qué opina al respecto?
Dos intérpretes no van a tomar las mismas notas, eso está claro. Y cada intérprete tomará las notas que más se adapten a sus necesidades. Sin embargo, las técnicas para hacerlo se pueden y se deben aprender. La toma de notas es una expresión de nuestro análisis del discurso de origen. Nadie sugeriría que no analizáramos un discurso, ¿verdad?
En la actualidad se han hecho numerosas investigaciones que demuestran que aprender un sistema de toma de notas ayuda a los estudiantes a desenvolverse mejor en una interpretación consecutiva (Andres, 2002). No puedo decirlo mejor que Maren Dingfelder (2015): «Décadas de investigación [...] han demostrado sobradamente que los estudiantes pueden beneficiarse y de hecho se beneficiarán de una introducción estructurada, consciente y sistemática a la toma de notas como una habilidad fundamental para la interpretación consecutiva» (p. 165).
Algunas técnicas, como la verticalidad, el escalonamiento o anotar los enlaces a la izquierda de la hoja, son utilizadas por la mayoría de los intérpretes, incluso por los que se oponen a la enseñanza de la toma de notas.
| Por Héctor Pavón Traducción:
¿Cómo se enseña la técnica de toma de notas en las universidades, al menos en los entornos que usted conoce?
Yo dicto un curso de metodología para todos los estudiantes, independientemente de la combinación lingüística que tengan, por lo que en gran parte enseño un enfoque estructurado y metodológico, algo de lo que hablaré en el VII Congreso. Otras universidades también intentan enseñar un método básico, pero son los estudiantes los que deciden cuánto van a usar ese sistema. Después de todo, ¡al finalizar el curso se califica a los alumnos por su interpretación consecutiva! ¡Jamás por la forma en que toman sus notas! Entonces, la toma de notas sigue siendo un medio para llegar a un fin.

| REVISTA CTPCBA | N.° 157 | ABRIL-JULIO 16 NOTICIAS DEL VII CONGRESO VII Congreso Latinoamericano de Traducción e Interpretación
traductora pública Denisse Filippi
¿Su método supone alguna diferencia si se trata de una interpretación consecutiva breve o más extensa?
No se trata solo de «mi» método, sino que más bien podría describirse como el método de Bruselas o el método de la Unión Europea. Mis libros y mi trabajo sobre la técnica de toma de notas para la interpretación consecutiva son una continuación y una extensión de un método que ya se encuentra en el libro de Roderick Jones (1998) titulado Conference Interpreting Explained. Sin embargo, los principios del método se remontan a Andronikoff y la década de los cincuenta (Ilg y Lambert, 1996).
¿Cómo fue variando la toma de notas a lo largo de la historia de la interpretación?
En los años cincuenta y en los sesenta, la principal preocupación de quienes enseñaban la técnica de toma de notas era que las notas fueran sucintas, es decir, que funcionaran como un estímulo para la memoria, en lugar de intentar registrar todo lo que se dijo. A menudo, la taquigrafía se mencionaba como un ejemplo para evitar a la hora de tomar notas. En los años ochenta, los autores estaban divididos entre aquellos que sí creían en los símbolos (y hasta cierto punto en un «sistema» de toma de notas) y aquellos que no. Los dos bandos estaban representados por Matyssek y Seleskovitch, respectivamente. Sin embargo, tal como lo explica Dingfelder en un ensayo excelente acerca de la historia de la toma de notas, en retrospectiva se puede ver que ambos bandos estaban enseñando los mismos principios generales. Asimismo, el estilo de Bruselas, sin lugar a dudas, también se enseñó durante los años ochenta, aunque no apareció en los libros sino hasta una década más tarde (¡al menos según los resultados de mi propia investigación bibliográfica sobre el tema!).
A aquellos interesados en más detalles acerca de la historia de la enseñanza de la toma de notas para la interpretación consecutiva les recomiendo que lean los trabajos de Dingfelder e Ilg.
Creo que también merece la pena abordar brevemente el término sistema de toma de notas. Según mi impresión, el término se ha malinterpretado. Aprender un «sistema» no significa que dos intérpretes deban tomar las mismas notas a partir del mismo discurso. Ni siquiera significa que el mismo intérprete deba tomar las mismas notas del mismo discurso en dos ocasiones distintas, sino que las notas se ajusten a una serie de técnicas que ofrezcan coherencia al intérprete. Este enfoque —por ejemplo, en cuanto a la ubicación de los elementos en la hoja de anotaciones— se pone en práctica hasta

que se vuelve automático y, por lo tanto, se requiere de un menor esfuerzo cognitivo para aplicarlo. Entonces, ese espacio cognitivo queda disponible para escuchar y analizar. Este enfoque también favorece la capacidad del intérprete de memorizar, analizar y recordar, y facilita la fluidez de la interpretación.

¿Qué clase de símbolos utiliza o aconseja que se utilicen para tomar notas?
No hay una respuesta correcta que se ajuste a todos los intérpretes. Los símbolos muchas veces no funcionan para algunos. Mi consejo general es que los símbolos son útiles para conceptos recurrentes que no pueden escribirse en breves palabras. Además, deben ser rápidos de escribir, fácilmente identificables e inequívocos. Hablé con más detalles al respecto en un video que se encuentra en YouTube: Symbols: dos and don’ts (https://youtu. be/tFvXuZfkx8o).
En su ya legendario libro sobre la técnica de toma de notas, Rozan (1956) recomienda no usar más de veinte símbolos. Yo conté los símbolos de mis notas y encontré entre treinta y cuarenta diferentes. Sin embargo, poner un tope no es el mejor enfoque, ya que muchos símbolos pueden combinarse para crear un significado diferente sin que el intérprete use un «nuevo» símbolo.
De hecho, este es el motivo por el que se asocia casi exclusivamente a Matyssek con el glosario de tres mil símbolos que creó y no con los útiles principios para tomar notas que también escribió en el mismo libro. En realidad, solo creó más de cien símbolos diferentes, pero luego los combinó de múltiples maneras y así terminó con una lista enorme.
17 REVISTA CTPCBA | N.° 157 | ABRIL-JULIO |
¿Qué medidas debe adoptar un profesional antes de llegar al lugar de trabajo, para evitar sorpresas?
Biografía de Andrew Gillies
Andrew Gillies es intérprete de conferencias y formador de intérpretes. Actualmente, reside en París. Interpreta del francés, alemán y polaco al inglés en el Parlamento Europeo, la Oficina Europea de Patentes y la Agencia Espacial Europea, entre otros. Es docente de interpretación en el ISIT en París y en la maestría en Interpretación de Conferencias de Glendon College, de la Universidad de York, en Toronto, y ha sido formador invitado en universidades de Polonia, Alemania y Portugal. También ha dictado cursos de formación continua (CPD) para intérpretes en el Parlamento Europeo, el Tribunal de Justicia de la Unión Europea, la AIIC, la ATA y en otras asociaciones profesionales. Además, es formador de docentes de interpretación.
Ha escrito mucho sobre la formación de intérpretes y ha publicado diversos artículos sobre la profesión para medios del sector. También es responsable de los sitios web Interpreter Training Resources (https://interpretertrainingresources.eu/) e Interpreters CPD (https:// interpreterscpd.eu).
En cuanto a la propia actividad del intérprete, los profesionales son relevados, es decir que son relevados tras un período de arduo trabajo. Luego retoman su lugar y continúan interpretando. Incluso pueden hacer más de una interpretación el mismo día, y de temas muy diferentes.

¿Cuánto se cansa el cerebro del intérprete? ¿Qué sucede con el intérprete que debe pasar de un idioma a otro, y luego a la inversa, cuando, por ejemplo, debe interpretar las preguntas de la audiencia al orador? Es un desafío diferente, ¿no? Y también es un desafío distinto cuando el intérprete debe trabajar con idiomas más exóticos y menos conocidos, ¿verdad?
En Europa hablamos de «idiomas de menor difusión», pero no creo que se pueda generalizar. En primer lugar, es mucho más sencillo si lo básico está cubierto: un conocimiento profundo e instantáneo del idioma y la cultura de origen, al igual que el dominio del idioma de llegada. Además, creo que las distancias culturales y gramaticales entre los idiomas marcan la diferencia. Desde un punto de vista europeo, el tailandés y el laosiano pueden considerarse «exóticos», pero interpretar entre ellos puede resultar más sencillo que interpretar de cualquiera de los dos al inglés. Habiendo dicho esto, el idioma inglés está más vinculado al alemán que al francés, pero algunos intérpretes europeos consideran
que es más difícil interpretar del alemán al inglés que hacerlo a otros idiomas.
Referencias bibliográficas
Andres, D. (2002). Konsekutivdolmetschen und notation. Peter Lang.
Dingfelder Stone, M. (2015). The theory and practice of teaching note-taking. En D. Andres y M. Behr (eds.), To know how to suggest... Approaches to teaching conference interpreting (pp. 145-169). Frank & Timme.
Ilg, G. y Lambert, S. (1996). Teaching consecutive interpreting. Interpreting, 1(1), 69-99.
Jones, R. (1998). Conference interpreting explained (1.ª ed.). St Jerome.
Rozan, J.-F. (1956). La prise de notes en interprétation consécutive. Georg.

| REVISTA CTPCBA | N.° 157 | ABRIL-JULIO 18
NOTICIAS
DEL VII CONGRESO VII Congreso Latinoamericano de Traducción e Interpretación
Andrew Gillies: «La toma de notas es una expresión de nuestro análisis del discurso de origen»

Lina Mundet:
Global, general, estándar, latino o panhispánico son todas denominaciones del español neutro o internacional, tema al que se referirá la especialista argentina Lina Beatriz Mundet en el VII Congreso. «El traductor buscará aclimatar su texto en un español acorde con el que usa la audiencia donde circulará el escrito», sostiene Mundet.

¿Qué diferencia hay entre el español internacional y el neutro?
Más que establecer diferencias, pienso que estamos hablando del mismo objeto de estudio. El español neutro o internacional es la supravariedad o variedad lingüística artificial que tiene como objetivo alcanzar a la mayor cantidad de hispanohablantes de forma eficaz mediante el uso dinámico de la lengua. Como tal, el español neutro o internacional carece de raíces geográficas, dado que no está atado a ningún lugar (no diatópico) y su empleo es comercial. La designación de neutro es más antigua y reconocible, por un mayor número de usuarios, que la de internacional. También posee un tinte más peyorativo, porque transitó por épocas que denostaron su uso. Este disvalor está asociado al verbo neutralizar, lo que genera un efecto negativo. Entre otras denominaciones del español neutro están el español global, general, estándar, latino, panhispánico...
¿Desde cuándo existe esta categorización del español?
Alejado del campo académico, el concepto de español neutro se origina por motivos puramente económicos y como consecuencia de la globalización del mercado hispanohablante, que prioriza la celeridad y el
| Por Héctor Pavón
abaratamiento de costos. No obstante, su origen es desconocido, se supone que proviene del ámbito audiovisual, donde se buscaba abaratar precios mediante el uso de una sola versión de subtitulado y de doblaje que se entendiera en toda Latinoamérica. No hay duda de que la cantidad masiva de usuarios requiere una estandarización terminológica que facilite el consumo.
¿Cómo se forma el traductor y el corrector profesional en el español internacional o neutro? ¿Qué herramientas y conocimientos debe adquirir?
Tanto el corrector como el traductor de textos en inglés son técnicos profesionales que formamos (por ejemplo) en el Instituto Mallea para una efectiva inserción en el mundo del trabajo. Sus competencias sobre la lengua española, por un lado, y la inglesa, por el otro, están consolidadas a partir de diversas perspectivas organizadas en espacios de aprendizaje como lo son la morfosintáctica (normativa y sintaxis), la semántica (significados y sentidos), la pragmática (adecuación y registro), la estilística (isotopías), la superestructural (géneros textuales), la macroestructural (esquemas de contenidos), la microestructural (mecanismos de cohesión) y la retórica (recursos persuasivos). Sin embargo, a pesar de poseer un perfil propio y diferenciado, corrector y traductor pueden
| REVISTA CTPCBA | N.° 157 | ABRIL-JULIO 20 NOTICIAS DEL VII CONGRESO VII Congreso Latinoamericano de Traducción e Interpretación
«El español neutro se alimenta del contacto entre culturas y espacios que permiten la conectividad actual para ampliar el léxico de todos los hispanohablantes»
vincularse en el momento de usar el español neutro. El traductor buscará aclimatar su texto en un español acorde con el que usa la audiencia donde circulará el escrito; el corrector o revisor de traducciones, a su vez, hará lo propio con las traducciones que supervisa. En esa instancia ambos son conscientes de la responsabilidad que significa poner en práctica la propuesta metodológica que les proponen las prácticas profesionalizantes de sendas tecnicaturas. Si la utilizan con tino, obtendrán una buena versión del texto traducido.
¿En qué situaciones surge el desafío de aplicar el español internacional o neutro en la corrección de textos que vienen del inglés?
Existen ámbitos de la cultura audiovisual que buscan abaratar los presupuestos a partir del uso de una sola versión de subtitulado o doblaje que pueda entenderse en todo el mercado hispanohablante. Por este camino, se evita la producción de múltiples versiones adaptadas a cada variante, que son numerosas, y que por dicha causa supondrían costos mayores. A partir de esta posibilidad, los ámbitos interesados crecen considerablemente: empresas multinacionales, editoriales, corporaciones audiovisuales (doblaje y subtitulado); medios de comunicación y periódicos digitales en español, entre otros. ¿La utilización del español internacional o neutro trajo resistencias? ¿Qué debates se han dado al respecto?
Hay posturas enfrentadas, dentro de los lingüistas y editores principalmente, que se oponen al uso del español neutro, porque contradice la pulcritud de la norma y no solo pone en riesgo, dicen, la riqueza de las variedades latinoamericanas, sino que también contribuye a la pérdida de los elementos culturales que conforman la identidad de un lugar. Esta posición politizada paraliza el uso del español neutro y dificulta la tarea de los profesionales.
Así, escuchamos voces que decretan que «el español neutro es un idioma que no existe... completamente utópico, porque hay tantos españoles neutros como personas lectoras, traductores y editores». Estas posturas inflexibles provienen de una corriente de pensamiento, hoy obsoleta, que concibe el español neutro como una selección rígida de palabras que no suenan naturales. Sin embargo, entiendo que la variedad internacional no busca entronizarse como la nueva normativa estándar ni como un idioma independiente que reemplace las variedades diatópicas en la vida diaria. Por el contrario, mi equipo de trabajo afirma que el español neutro se

alimenta del contacto entre culturas y espacios que permiten la conectividad actual para ampliar el léxico de todos los hispanohablantes.
Vivimos en una época en la que se producen nuevas palabras de modo frecuente, las cuales los lectores adquieren velozmente. ¿Cómo vive este proceso el corrector y el traductor profesional al poner en práctica el español internacional o neutro?
A contrapelo de los puristas a ultranza, considero que la utilización del español internacional o neutro no es una renuncia a las múltiples variantes que ofrece la lengua; por el contrario, se abre a las variadas audiencias, enlaza culturas, enriquece el acervo lingüístico y, por tanto, deberá usarse en aquellos textos que se consumen en forma masiva y que necesitan transparentar los posibles baches que puedan producir los modismos locales en pos de rescatar el sentido de lo que se lee o escucha. En consecuencia, se incorporan palabras al patrimonio idiomático de los hablantes y, en lugar de empobrecer el vocabulario, lo alimenta. Así sucede con palabras como fresa, pastel y mando, que se incorporaron al vocabulario de los argentinos a través de la selección neutra, pero que no reemplazaron las voces propias de la región en el uso oral (frutilla, torta, control).
El español neutro se consume constantemente en libros, series y películas y, aun así, nadie lo usa en la vida diaria. Esto es porque, por un lado, las obras de calidad

21 REVISTA CTPCBA | N.° 157 | ABRIL-JULIO |
Lina Beatriz Mundet: «El español neutro se alimenta del contacto entre culturas y espacios que permiten la conectividad actual para ampliar el léxico de todos los hispanohablantes»
imaginativa, dentro del campo del arte, tienen la virtud de sobreponerse a la mera comunicación idiomática y, por otro, responde a un objetivo específico comercial que no tiene la capacidad de reemplazar una variante diatópica existente; en todo caso, como ya afirmé, la enriquecerá. Y, finalmente, como este mecanismo hace un uso dinámico del español y de todas sus variantes para existir y realizarse, se ve afectado por los cambios y la evolución que supone una lengua viva, una lengua que mantiene la «unidad dentro de la diversidad».
¿Las nuevas tecnologías de traducción y corrección electrónica han tomado en cuenta el español internacional o neutro?
Biografía de Lina Mundet


Lina Beatriz Mundet es profesora y licenciada en Letras, y magíster en Comunicación, egresada de la Universidad CAECE. Se desempeñó como becaria interna del CONICET (Consejo Nacional de Investigaciones Científicas y Técnicas), donde profundizó en la obra del escritor argentino Eduardo Mallea. Desde 1989 es rectora-fundadora del Instituto Superior de Letras Eduardo Mallea, para el que creó las carreras de corrector literario y redactor especializado, en sus opciones presencial y a distancia, ambas con título oficial de validez nacional. Por dicha labor, el Gobierno de la Ciudad de Buenos Aires le otorgó el premio Mujer Notable 2005. Entre otros reconocimientos recibió, en 2014, de AREPRA (Asociación de Rectores de la República Argentina), el de magister laudet y, en el Congreso Nacional de Educación en Puebla (México), el de doctor honoris causa cum laude. En la actualidad, prepara la defensa oral de su tesis de doctorado en Educación, de la UNINI-MX (Universidad Internacional Iberoamericana).
Sí, por supuesto que sí; con el tiempo se han ido perfeccionando en este aspecto. Noto que, al ser inclusiva la variante neutra, las nuevas tecnologías recurren al español y a todos sus dialectos para realizar elecciones léxicas y morfosintácticas más accesibles. No hay duda de que se piensa en un consumidor global del español y que el uso de la variante internacional lo hace más comunicativo e inteligible. Por el contrario, si recibimos de los formatos electrónicos un español muy marcado por el acento peninsular, por ejemplo, tendremos una comunicación disruptiva, sin dudas, rechazada por la mayoría de los usuarios.
A pesar de esto, el traductor o el revisor de traducciones que tome el material de la tecnología adaptará el texto resultante a la audiencia a la que pretende dirigirlo, con la conciencia de que realizar el trasvase requiere formación lingüística y pericia.
¿Se ha enfrentado al desafío de corregir casos de lenguaje inclusivo en el español internacional o neutro? ¿Cómo lo resolvió?
Debido a que el español neutro posee carácter internacional, no es incompatible con una selección léxica o estructural fija. Esto quiere decir que no hay, en realidad, soluciones preestablecidas para cada caso, sino opciones de corrección sobre las que el profesional deberá tomar decisiones.
En los espacios de la práctica del Instituto Mallea, se ensayan varias posibilidades de aplicación del español neutro basadas en una guía metodológica, especialmente armada para que los alumnos puedan reflexionar sobre ella y enriquecerla a partir de la metacognición o del conocimiento generado en la reflexión sobre la práctica. ¿El uso del español internacional o neutro puede acarrear problemas en la composición de un texto y en su redacción final?
El profesional de la escritura o redactor que pretenda usar el español neutro o internacional en sus escritos deberá tomar decisiones que, guiadas por el rigor profesional y la ética, velarán por la calidad y la función comunicativa del texto. Por esta razón, una vez estudiado el perfil de sus posibles lectores, necesitará contar con una especie de guía o encuadre metodológico que lo potencie en la toma de decisiones, lo provea de herramientas y lo encamine en su tarea de redacción. Con este bagaje de recursos, posiblemente pueda vencer los obstáculos que se le presenten en el momento de dar cuerpo a su texto.
| REVISTA CTPCBA | N.° 157 | ABRIL-JULIO 22
NOTICIAS DEL VII CONGRESO VII Congreso Latinoamericano de Traducción e Interpretación
Miguel Duro Moreno:
«En el futuro, la traducción oficial también se verá afectada por tecnologías como las del metaverso o la web 3»

Miguel Duro Moreno, traductor e intérprete de la Universidad de Málaga, hablará en el VII Congreso organizado por el CTPCBA sobre el uso de nuevas y disruptivas tecnologías (cadena de bloques o blockchain) para las traducciones oficiales. Sostiene que esta iniciativa siempre irá en función de «avanzar en la veracidad, la seguridad y la trazabilidad de la cadena de custodia de los productos traducidos respecto de sus respectivos originales». Es decir, se trata de garantizar la calidad del trabajo y la atribución de la autoría de lo traducido a sus correspondientes autores dentro de la cadena de valor.
| Por Héctor Pavón
¿Qué cambios importantes ha tenido la traducción oficial en los últimos años que hayan modificado el trabajo de los traductores profesionales?
En esencia, la digitalización de la traducción como producto y como proceso (en particular, por las restricciones impuestas por el confinamiento que siguió al estallido de la pandemia de COVID-19 hace ahora justo tres años). La traducción oficial —vamos a llamarla así, para abreviar— ha sido siempre una actividad caracterizada más por el uso que se hacía del producto resultante de ella que por el campo de conocimientos que el profesional abordaba al ejecutarla, y lo habitual era que este último trabajara de forma analógica (esto es, con mucho soporte físico en forma de papel o cartulina, sellos en tinta o en seco o en relieve, timbres, emblemas, logotipos y hasta cintillos). El confinamiento cambió, en buena medida, todo eso en diversos países del ámbito panhispánico, aunque es muy cierto que en otros, como España, bastantes traductores jurados ya trabajaban antes de la aparición de la pandemia con medios exclusivamente digitales (incluidas la firma digital propiciada por el certificado electrónico y la estampa digitalizada de su sello). Faltan muchas cosas por hacer, en todo caso, sobre todo si se quiere avanzar en la veracidad, la seguridad y la trazabilidad de la cadena de custodia de los productos traducidos respecto de sus respectivos
originales, en el aseguramiento de la calidad de aquellos y en la atribución de la autoría de lo traducido a sus correspondientes autores dentro de la cadena de valor, porque hay tecnologías, como la de la cadena de bloques, que permiten llevarlo a cabo.
¿Qué resultados está teniendo su proyecto de cartografiar la traducción oficial en el mundo panhispánico?
Estamos, actualmente, en la fase inicial, consistente, por una parte, en dar a conocer el proyecto en los ámbitos científico y profesional, y, por otra, en seleccionar a los colaboradores que van a hacerse cargo de cada país o territorio hispanohablante objeto de análisis y elaborar los cuestionarios y las entrevistas semiestructuradas que nos servirán para medir cuantitativamente el objeto de estudio. El proyecto lo he querido plantear desde el primer instante desde una perspectiva deliberadamente panhispánica que huyera del tan manido punto de vista eurocéntrico, y por ello está codirigido, en pie de igualdad, por mi colega Mary Ann Monteagudo Medina, decana del Colegio de Traductores del Perú y titular, en la actualidad, de la presidencia de FIT LatAm. El número de investigadoras que en él participan —todas son mujeres— es mayoritariamente hispanoamericano.
23 REVISTA CTPCBA | N.° 157 | ABRIL-JULIO |
¿A qué se refiere con el uso de nuevas y disruptivas tecnologías en traducciones oficiales? ¿Podría explicárnoslo brevemente?
El proyecto persigue un dúplice objetivo: en primer lugar, cartografiar la traducción oficial —insisto en que prefiero denominarla así para abreviar, porque no toda traducción oficial es la que llevan a cabo los traductores-intérpretes jurados, sino que también lo es la consular, la bendecida por los jueces o secretarios judiciales, la dada por buena por notarios o registradores, la realizada por los funcionarios de las administraciones públicas, etcétera— en todo el vasto mundo panhispánico (y eso incluye tres continentes: Europa, por España; África, por Guinea Ecuatorial; y América, por la miríada de países o territorios hispanohablantes, incluidos los Estados Unidos); y, en segundo lugar, proponer el uso de diversas tecnologías que, tras el correspondiente estudio de viabilidad a la hora de aplicarlas, rompan con lo puramente analógico —el papel y la cartulina, inter alia— y permitan digitalizar todo el proceso de la traducción oficial ab ovo usque ad mala (esto es, desde el principio hasta el fin) y asegurar, en particular, la calidad, la veracidad, la trazabilidad, la atribución de autoría y valor de lo vertido, la ausencia de manipulaciones y falsificaciones de todos los productos generados a partir de él. La cadena de bloques (blockchain) permitiría garantizar, a un coste aún por determinar, que la actividad de la traducción jurada la llevaran a cabo, con los parámetros antes citados, los profesionales que tuvieran las competencias para ello. Habría que dotarlos de una red cerrada (es decir, en la que pudiera operar únicamente un número determinado de usuarios: los traductores jurados de una determinada asociación profesional o un colegio, por ejemplo) y de un protocolo de consenso barato y rápido que permitiera trabajar con comodidad y de forma casi invulnerable. Eso es lo que podría aportar la tecnología disruptiva de la cadena de bloques. En el futuro, la traducción oficial también se verá profundamente afectada, casi con toda seguridad, por el advenimiento de otras tecnologías que ahora nos parecen tan disruptivas o más que esta última —como las del metaverso o la web 3—, pero que más pronto que tarde dejarán de serlo. Es harto probable que dentro de algunos años el traductor oficial se encuentre con su cliente en el metaverso y allí ejecute y perfeccione todas las operaciones que conlleve un encargo profesional. Ahora mismo parece un producto de la ficción científica, pero pronto será una realidad asumida por casi todos (siempre habrá quien desee seguir funcionando en el universo que todos conocemos).

¿Por qué sostiene que la traducción oficial es una actividad más marcada por el uso que por el campo?
La traducción oficial se caracteriza, fundamentalmente, por el uso que el cliente o el destinatario hagan de ella (es bastante habitual que ambas figuras no coincidan en la misma persona, física o jurídica). Constituye, pues, una actividad teleológicamente determinada: siempre que se encarga es para conseguir algo con ella. Pongamos un ejemplo: si uno se ha casado en Las Vegas y, contra todo pronóstico, no se arrepiente a la mañana siguiente, sino que, muy al contrario, desea hacer valer el matrimonio en su país o territorio de origen, debe encomendar a un traductor oficial (jurado, público, juramentado, etcétera) que vierta al idioma del ordenamiento jurídico correspondiente la documentación en la que se ha plasmado el acto jurídico del himeneo; los actores involucrados son tres, como mínimo: el cliente (el recién casado), el traductor oficial y la administración pública destinataria de dicha documentación (por lo general, el registro civil). Lo que importa en el ejemplo es el uso que el cliente hace de la traducción: la quiere para algo (para que surta efecto) y por eso la encarga al traductor oficial. Este, a la hora de ejecutarla, firmarla y sellarla, ha de tener presentes todos los entornos que determinan la actividad que está llevando a cabo para que el producto resultante le sea útil al cliente y cumpla los fines oportunos perseguidos ante el destinatario último. Por lo demás, el traductor oficial también tiene que dominar el campo de conocimientos que aflore en la traducción: en nuestro ejemplo, el derecho de familia (e incluso el registral).
| REVISTA CTPCBA | N.° 157 | ABRIL-JULIO 24
Miguel Duro Moreno: «En el futuro, la traducción oficial también se verá afectada por tecnologías como las del metaverso o la web 3»
NOTICIAS DEL VII CONGRESO VII Congreso Latinoamericano de Traducción e Interpretación
¿En qué consiste la transformación intensa a causa de la pandemia de COVID-19 en el uso de tecnologías?
Como ya he dejado indicado, el confinamiento cambió muchas cosas para mucha gente desde el punto de vista laboral o profesional, y no siempre del modo más adecuado. En el caso de la traducción oficial, forzó a bastantes colegas a digitalizarse, dado que, al estar encerrados durante meses, no podían continuar ejerciendo su actividad de la forma tradicional: de lo analógico tuvieron que migrar a lo digital, y de lo presencial, a lo virtual. Algunos colegios profesionales aprovecharon la circunstancia para impulsar la firma digital de sus miembros. Una vez concluido el confinamiento, esos hábitos de trabajo continuaron en más casos de lo que uno podría llegar a pensar. Hoy es bastante frecuente que toda la actividad de la traducción oficial se desarrolle por medios exclusivamente digitales, en todas sus dimensiones, y que ni la calidad del producto resultante ni la seguridad de lo traducido respecto de su original se vean alteradas, amenazadas o mermadas.
¿En qué consiste el objetivo de aplicar tecnologías nuevas, novísimas y disruptivas a la traducción oficial?
Miguel Duro Moreno es diplomado, licenciado con correspondencia en máster y doctor en Traducción e Interpretación por la Universidad de Granada. También es licenciado con correspondencia en máster en Filología Semítica por la misma institución de educación superior. En el año 2000 obtuvo el nombramiento como traductor-intérprete jurado (equivalente al de traductor público) para el idioma inglés del Ministerio de Asuntos Exteriores y Cooperación de España. Posee más de treinta años de experiencia en la práctica profesional y la docencia universitaria de la traducción. Ha impartido clase en una veintena de universidades repartidas en tres continentes y, en la actualidad, enseña e investiga en el Departamento de Traducción e Investigación de la Universidad de Málaga, donde es profesor titular y coordinador del perfil lingüístico de inglés y del máster universitario en Traducción para el Mundo Editorial. También es el fundador (y ahora decano honorario) del Hieronymus College de Woolf University (Estados Unidos). Sus líneas de trabajo fundamentales se centran en el derecho comparado para la traducción jurídica y jurada, en el uso de herramientas informáticas gratuitas y eficaces aplicadas a la traducción jurídica y jurada, así como en la lingüística coseriana de los entornos reformulada como modelo traductológico. Es autor de más de medio centenar de publicaciones especializadas, entre libros, capítulos y artículos, y dirige la colección Derecho, Discurso y Traducción de la editorial de materiales jurídicos Edisofer (Madrid). Es miembro de varias asociaciones que tienen por objeto la defensa de los intereses de los profesionales de la traducción y la interpretación jurídica, jurada y judicial.

No es más que una propuesta. Se trata de eliminar lo analógico (el papel, el sello, la tinta, el timbre, el cintillo, etcétera) y reemplazar cada uno de esos elementos por su respectivo equivalente digital, sin merma de la calidad o de la seguridad. La propuesta parte del principio de la aplicabilidad y la viabilidad: no todos los países o territorios estarán igualmente preparados (o incluso dispuestos) para aceptar los cambios tecnológicos en una primera fase, pero es evidente que, antes o después, habrán de adaptarse a los vientos que soplen si estos llevan consigo la digitalización de la actividad de la traducción oficial en alguno de sus múltiples planos.
¿Y de qué modo se preservan al mismo tiempo los aspectos éticos inherentes a la actividad?
Toda actividad profesional está, o debería estar, radicalmente condicionada por unos principios éticos inesquivables. La de la traducción, en especial. Y la de la traducción oficial, más aún. Sería, pues, conveniente que de los
tres enfoques fundamentales de la ética (el teleológico o consecuencialista, el deontológico y el de la virtud) el traductor oficial optara por uno y se rigiera por él ora para cada caso en concreto, ora para todo su devenir profesional. Los colegios y las asociaciones profesionales suelen dotarse de un código basado en un enfoque deontológico (el cual insiste en que algo debe hacerse de determinada manera sin tener en cuenta las consecuencias que de ello se deduzcan), pero el traductor autónomo no colegiado o asociado —cuando ello sea posible porque así lo permita el ordenamiento de un país o territorio concreto— tiene a su disposición los otros dos. El primero, el teleológico, le enseña que las consecuencias derivadas de algo que ha hecho con un fin son mejores que las dimanantes de cualesquiera otras derivadas de otros actos por acción u omisión. El tercero, en fin, plantea que hay un modelo de actuar virtuoso hacia el cual hay que tender activamente, puesto que es el más adecuado para desarrollar la actividad profesional.
25 REVISTA CTPCBA | N.° 157 | ABRIL-JULIO |
Biografía de Miguel Duro Moreno
El pensamiento vivo de los protagonistas del VII Congreso
Aquí presentamos un resumen de las reflexiones de algunos de los invitados al VII Congreso que fueron entrevistados en nuestra revista. En los últimos dos años, han abordado el mundo de la traducción y sus alrededores, la teoría y la práctica, la escena académica argentina y la del mundo entero, el panorama de la interpretación, la corrección de textos, entre muchos otros campos de interés.

Rosa Llopis:
«No debemos olvidar jamás que para el cliente la traducción es un problema, y nosotros venimos a solucionárselo, no a crearle nuevos problemas»
La traductora e intérprete española Rosa Llopis suele ofrecer sugerencias y consejos sobre cómo abrirse camino en el competitivo mundo de la traducción a quienes se inician en la profesión. Llopis se especializa en el área de la gastronomía y, además, es una de las pocas profesionales en el mundo de la lengua valenciana: ambas especialidades la volvieron una experta muy valorada.

Conseguir un primer trabajo es un desafío. ¿Cómo se hace «visible» un traductor novel? ¿Cómo se «vende», se publicita un joven traductor? ¿Cómo puede distinguirse y qué aspectos debe subrayar cuando ofrece sus servicios?
Cuando estaba estudiando la carrera, leí un artículo de Pablo Muñoz en su blog Algo más que traducir, en el que afirmaba que todos tenemos algo que nos diferencia de los demás. Recuerdo que aquel mensaje me llegó al alma y nunca lo he olvidado. Eso es lo que tenemos que explotar al principio: aquello que nos diferencia, aquello que podemos aportar y los demás no. Al comienzo, pensaba que debía explotar el hecho de venir de una familia de abogados, pues la traducción jurídica se me daba bien. No obstante, lo que realmente me ha abierto las puertas han sido dos rarezas. La primera, que hablo una lengua
minoritaria (valenciano), así que se lo contaba a todo el mundo. Y funcionó. Cada vez que alguien sabe de un proyecto con esa combinación lingüística tan poco habitual, me llama. Y gracias al valenciano comencé a interpretar en televisión y radio. Mi segunda rareza es que me he criado en la pastelería de mis abuelos, y la cocina es un mundo que me encanta. Un día, invité a unos compañeros traductores a cenar a mi casa, y hablamos de esto porque les sorprendió lo bien que cocino. Al cabo de unas semanas, uno de los invitados me llamó porque en la escuela de alta cocina francesa Le Cordon Bleu estaban buscando intérpretes especializados en cocina. Y, por otro lado, ¿cómo llegar a otros traductores? Pues asociándose, acudiendo a encuentros, a formaciones, a congresos. Al igual que al cliente hay que salir a buscarlo, a los compañeros también.
Biografía de Rosa Llopis
Rosa Llopis es graduada en Traducción y Comunicación Intercultural y máster en Interpretación de Conferencias por la Universidad Europea de Valencia, especializada en traducción e interpretación gastronómica. Ha trabajado como intérprete para Le Cordon Bleu y en clases privadas de cocina y charlas sobre gastronomía. Es miembro de la Asociación Española de Traductores, Correctores e Intérpretes (Asetrad) y de la Red de Traductores e Intérpretes de la Comunidad Valenciana (Xarxa TIV).
| REVISTA CTPCBA | N.° 157 | ABRIL-JULIO 26 NOTICIAS DEL VII CONGRESO VII Congreso Latinoamericano de Traducción e Interpretación
| Por Héctor Pavón
Antonio Martín:
«No somos “la infantería de la RAE”, sino que estamos al lado de los lectores»
El filólogo y experto Antonio Martín explicó cómo se ha transformado el trabajo del corrector y ampliado el campo laboral. También se refirió a una convivencia con la tecnología en la que sepamos aprovechar sus herramientas y recursos, como, por ejemplo, la corrección en pantalla y las múltiples posibilidades que hoy tiene el profesional para realizar su labor con eficiencia.

¿Cómo juega hoy el concepto de purismo en un contexto tecnológico tan marcado?
«El purismo es una bandera que destiñe pronto». Esa es mi respuesta favorita. El purismo se cura con la edad. Ser purista responde a la lógica necesidad de contar con un orden claro, una sola norma, donde está siempre claro lo que está bien o mal, prescindiendo del contexto. Siguiendo con el ejemplo de la abogacía, siempre podríamos pensar que la justicia se podría dejar en manos de computadoras, pero es el factor humano el que detecta los matices y el contexto para tomar decisiones. En este sentido, es preciso que las Academias valoren la aportación del lenguaje computacional: los datos que me da
Xosé Castro Roig:
«La tecnología es un tren en marcha. Hay que vigilarla de cerca, porque no espera por nadie»
Xosé Castro Roig, traductor y corrector (entre muchas otras profesiones y oficios), contó cómo organiza su intensa vida laboral y propuso actitudes para tener en cuenta en el mundo de la traducción audiovisual, en particular, y en la profesión, en general.
Hoy parece que ya estuviéramos ingresando en un nuevo mundo con reglas de trabajo renovadas, cambiadas. ¿Qué cosas cree que debería tener en cuenta el traductor novel, el ya asentado y el experimentado en cuanto a su proyección profesional y a un «nuevo» marketing?
El adagio Littera scripta manent sigue ahora incluso más vigente: todo lo que haces en internet permanece, así que conviene dejar una huella positiva (o de la que no te arrepientas demasiado), especialmente los traductores más jóvenes, para quienes la línea que separa lo personal de lo profesional se antoja más difusa. La tecnología es un tren en marcha. Hay que vigilarla de cerca, porque no espera por nadie. En un mundo tan diverso
Google Ngram Viewer o Google Trends los podrían estar usando ya estas instituciones para saber si una palabra se dice de un modo u otro, y dónde y cuándo está pasando: si tengo que decidir si se escribe «friegasuelos» o «fregasuelos», las Academias me dan una respuesta normativa; la tecnología me dice lo que están haciendo los hablantes con esas palabras en un área geográfica determinada.
Biografía de Antonio Martín
Antonio Martín es licenciado en Filología Hispánica por la Universidad Complutense de Madrid. Es director gerente de Cálamo & Cran y cofundador de PublishNews, EnClaro (Encuentros sobre lenguaje claro), UniCo (Unión de Correctores) y SEA (Spanish Editors Association). Además, es miembro de Palabras Mayores y socio de honor de la Casa del Corrector, de la Fundación Litterae. Es colaborador de Radio Nacional de España (RNE) en De Pe a Pa. Las mañanas de RNE y miembro del consejo editorial de la revista Archiletras. Es coautor de El libro rojo de C&C, 199 recetas infalibles para expresarse bien, Dilo bien y dilo claro, y autor de La mano invisible. Confesiones de un corrector iconoclasta.

y globalizado, hay que idear nuevas maneras de llegar a los clientes: crear soluciones, diversificarse, ofrecer más que pedir, generar contenido. Pero hay algo inmutable en nuestra profesión: nuestra presencia. Debemos estar presentes (hacernos ver, participar, visitar) física o digitalmente no solo para el cliente, sino para otros colegas. No es fácil conseguir clientes siendo una ermitaña. Algunos de mis mejores clientes los he conseguido gracias a recomendaciones o pistas de colegas.

Biografía de Xosé Castro Roig
Desde 1990, trabaja como traductor de inglés, corrector de estilo y redactor creativo. Está especializado en traducción técnica y en tecnología, electrónica, fotografía, localización de software, marketing, turismo, hoteles y recursos humanos, entre otras cosas. Ha traducido un gran número de series y películas para cine y televisión, tanto para doblaje como subtitulación, especialmente destinadas al mercado europeo (Spider-Man, Matrix...). Es creador y moderador de TRAG, la mayor lista electrónica de debate para traductores audiovisuales de habla hispana.
27 REVISTA CTPCBA | N.° 157 | ABRIL-JULIO |
Patrick Zabalbeascoa:
«La traducción es como el buen vino, mejora con el tiempo y tiene un tiempo mínimo razonable de realización»
El filólogo y traductor Patrick Zabalbeascoa aseguró que, durante la pandemia, el campo de la traducción audiovisual amplió su volumen de trabajo y que también se ha producido un cambio profundo en el concepto de televisión y de cine.
¿Cuál ha sido el cambio fundamental de los últimos tiempos en cuanto a la traducción audiovisual? ¿El consumo de series y películas en todo el mundo? ¿Un público más exigente?
Creo que el cambio más fundamental ha sido el de la gradual aplicación de la tecnología informática a todos los aspectos y fases de la traducción, desde su concepción hasta su recepción y consumo por parte de los espectadores. La globalización es otro gran factor y, aunque siempre ha habido una voluntad de exportación masiva del cine, el nivel con el que se produce en la actualidad supone un salto cualitativo, determinado por la disponibilidad de plataformas de internet, un amplio abanico de dispositivos de alta tecnología, cambios en cuanto a la velocidad de transmisión de datos y contenidos audiovisuales, y el aumento de la capacidad de almacenamiento. Los traductores audiovisuales se han
Manuel Ramiro Valderrama:
«El qué, cuándo, cómo de la traducción intraidiomática translectal»
En esta entrevista, el especialista aseguró que «las lenguas manifiestan una doble dinámica. Internamente, se configuran como sistemas semióticos que obedecen a leyes propias. Externamente, se desarrollan dentro de comunidades idiomáticas, que pueden coincidir o no con los límites territoriales de una nación».
¿Por qué dice que los idiomas tienen dos dimensiones, la interna y la externa?
Las lenguas manifiestan una doble dinámica. Internamente, se configuran como sistemas semióticos que obedecen a leyes propias. Externamente, se desarrollan dentro de comunidades idiomáticas, que pueden coincidir o no con los límites territoriales de una nación. Si trascienden las fronteras, asumen rasgos de las culturas de las que subtienden. Así ocurrió con el latín, con el castellano y con el inglés, por dar algunos ejemplos. El latín se fragmentó en las diversas lenguas románicas, mientras que el castellano y el inglés conservaron cierta unidad dentro de la diversidad diatópica o geolectal. El
beneficiado, en parte, por el gran volumen de productos audiovisuales que hay que traducir, lo que conlleva una gran oferta de trabajo. La digitalización ha cambiado su modo de trabajar, o quizás sea más exacto decir que la pandemia ha acelerado algunas tendencias que ya se habían iniciado, como es el teletrabajo, un elemento fundamental en la culminación de la globalización de la traducción audiovisual.
Biografía de Patrick Zabalbeascoa
Patrick Zabalbeascoa es catedrático de Traducción por la Universitat Pompeu Fabra, donde trabaja en el Departamento de Traducción y Ciencias del Lenguaje desde 1994. Se doctoró en Filología Inglesa, especialidad de traducción, por la Universidad de Lleida (1993) con la primera tesis doctoral en España sobre traducción audiovisual y acuñó el término texto audiovisual. Es docente universitario en asignaturas de traducción desde 1988. Sus trabajos de investigación versan sobre diversos aspectos de la traducción audiovisual, principalmente: el humor, la metáfora, la formación de traductores y la teoría de la traducción. Ha organizado varios congresos internacionales sobre traducción audiovisual y otros temas relacionados con la traducción, como ClipFlair Conference 2014, Taboo Conference 2016, Cita4 y Premios ATRAE 2016, y el Primer Congreso Hispanoamericano de Traducción Audiovisual en 2018, en Buenos Aires.

español es un caso especial, porque su unidad ha resistido el embate natural de su dilatada expansión territorial. En castellano, unidad y pluralidad se conjugan armoniosamente. Lo cual no quiere decir que no puedan plantearse y que no se planteen, de hecho, problemas de intercomprensión entre hablantes transgeolectales.
Biografía de Manuel Ramiro Valderrama
Manuel Ramiro Valderrama es maestro nacional argentino, profesor en Letras egresado de la Pontificia Universidad Católica Argentina Santa María de los Buenos Aires, licenciado en Filosofía y Letras —Sección Filología Hispánica— egresado de la Universidad Complutense de Madrid, y doctor en Filología Hispánica, egresado también de la Facultad de Filología de la Universidad Complutense de Madrid. Fue creador y primer decano (1995-2004) de la Facultad de Traducción e Interpretación en la Universidad de Valladolid en Soria. También es profesor titular jubilado de Traducción e Interpretación. Impartió las asignaturas de Lengua Española I y II, y Teoría y Práctica de la Producción Textual en la Facultad de Traducción e Interpretación de Soria.

| REVISTA CTPCBA | N.° 157 | ABRIL-JULIO 28 NOTICIAS DEL VII CONGRESO VII Congreso Latinoamericano de Traducción e Interpretación
El pensamiento vivo de los protagonistas del VII Congreso
Aída Kemelmajer de Carlucci:
«Hay que cumplir con lo debido, no decepcionar al cliente, al colega, a los alumnos. Ese cumplimiento requiere esfuerzo; nada viene de arriba»
La jurista Aída Kemelmajer, quien fue miembro de la Suprema Corte de Justicia mendocina, se refirió a su formación, su relación con distintos idiomas, su participación clave en las Comisiones de Reforma del Código Civil argentino y su entusiasmo por la traducción al francés del Código Civil y Comercial de la Nación, que fue realizada por las colegas Beatriz Rodriguez y Alide Drienisienia.

En su amplia experiencia, ¿le tocó trabajar con traductores públicos? ¿Alguna vez tuvo algún caso en el que se presentara un testimonio en una lengua poco conocida o frecuente?
Esta fue mi primera experiencia de trabajo con traductores públicos. Alguna vez, en congresos internacionales en los que existía interpretación simultánea, he tenido relación con los traductores para aclarar algunos conceptos jurídicos, pero la verdadera y extraordinaria experiencia la he tenido con la traducción del Código. La experiencia más cercana a la que me plantea fue en China. La traductora era una estudiante de la universidad; ella, incluso, tradujo el Power Point con el que apoyé
Betty Cohen:
«La pandemia generó una enorme necesidad de comunicaciones que, al menos en Canadá, implicó un gran aumento de la demanda de traducción»
Betty Cohen, expresidenta de la Federación Internacional de Traductores (FIT), se refirió a las nuevas tecnologías, la forma en la que cambian los métodos de trabajo en la traducción y los peligros del empobrecimiento de la lengua como consecuencia. En esta entrevista también analizó la competencia de las agencias de traducción, la investigación terminológica, el auge de la traducción automática, entre otros puntos. Sobre este último concluye que «la responsabilidad del resultado queda en manos del traductor, no de la máquina».
¿Cómo encuentra la situación actual de los traductores e intérpretes en términos de protección y reconocimiento?
Es ambivalente. La situación empeoró con la aparición de las tecnologías, de las grandes compañías de localización, etcétera, y a algunos traductores, directamente, se los explota. Sin embargo, últimamente hemos visto surgir sentencias judiciales, protestas e investigaciones que parecen ir en el sentido de un mayor reconocimiento de
mis clases. Tuvimos un arduo trabajo previo, porque a la formación jurídica incompleta de mi gentil traductora se sumaba la inexistencia de algunos conceptos básicos en la lengua china para poder explicar el sistema, como, por ejemplo, la noción de «constitucionalización del derecho privado».
Biografía de Aída Kemelmajer
Aída Kemelmajer es doctora en Derecho y Ciencias Sociales por la Universidad de Mendoza. Fue jueza de la Suprema Corte de Justicia de la Provincia de Mendoza (1984-2010). Es doctora honoris causa de diversas universidades públicas y privadas de la Argentina y del Perú, y de la Universidad de París XII, en Francia. Integró la comisión redactora del Código Civil y Comercial de la República Argentina, vigente desde el 1.º agosto de 2015. Integra el Comité Nacional de Ética en Ciencia y Tecnología y el Comité Científico de la Union Internationale des Huissiers de Justice. Fue parte de la Comisión de Estudios para la Unificación de las normas procesales de UNIDROIT y del grupo Unesco (París-Nueva York) sobre el principio de precaución. Dictó cursos de posgrado en América Latina y Europa. Fue distinguida con el Premio Konex de Brillante 2016 (humanidades) y el Premio Konex de Platino 1996 (derecho civil), 1998 (jueces) y 2016 (derecho civil).

las profesiones de traductor y de intérprete. El asunto de Netflix con El juego del calamar, básicamente, puso de manifiesto la muy escasa remuneración que perciben los traductores de subtítulos. Esperemos que este tipo de denuncias continúen. Por otro lado, la situación siempre varía de un país a otro y de un área a otra. Los profesionales deben mantenerse firmes y no aceptar todo.
Biografía de Betty Cohen
Betty Cohen es traductora jurada especializada en finanzas. Entre 2002 y 2005 fue presidenta de la FIT. Es licenciada en Traducción por la Universidad de Montreal y obtuvo un DEA en Ciencias del Lenguaje por la Universidad de París XIII Nouvelle Sorbonne. Entre sus logros figura el primer léxico de fraseología en el ámbito financiero, la Lexique de cooccurrents. Bourse et conjoncture économique, publicada por primera vez en 1986. En 2011 se publicó una nueva edición revisada y ampliada. Tras una carrera que la llevó de traductora autónoma a socia responsable de los servicios lingüísticos de una importante empresa de contabilidad, volvió a una de sus actividades favoritas: enseñar. Es formadora en traducción financiera, así como consultora en gestión de procesos y calidad.
29 REVISTA CTPCBA | N.° 157 | ABRIL-JULIO |
Christiane Nord:
«El significado es lo que nos da el diccionario, mientras que el sentido es lo que se forma en las mentes de los receptores»
La gran filóloga y traductora alemana Christiane Nord sufrió las consecuencias del confinamiento por la COVID, pero también le encontró beneficios. Defiende a ultranza el trabajo del traductor profesional y sostiene que, en la traducción electrónica, las máquinas solo ven el significado, «pero nosotros pensamos en el posible sentido que algo puede tener para el público destinatario».
¿La globalización, el siglo xxi marcado por la tecnología, las innumerables formas que tenemos de comunicarnos hoy han creado o incentivado una audiencia, un receptor o lector más exigente que afecta directa o indirectamente al traductor?
No creo que los lectores o receptores sean más exigentes, desgraciadamente. Mi impresión es que, al revés, la avalancha de textos mal escritos (o mal traducidos, quizás por sistemas automáticos) lleva a que cualquiera acepta lo que ella o él piensa es el «uso» general. Esta situación efectivamente afecta al traductor en que lo incentiva a enfatizar su USP (unique selling point) o argumento exclusivo de venta frente a las máquinas: nuestra competencia es saber qué decir, cómo, en qué situación, para quién y para qué propósito. Las máquinas solo ven el significado, pero nosotros pensamos en el posible sentido que algo puede tener para el público destinatario.
Biografía de Christiane Nord
Christiane Nord es traductora de alemán, español e inglés y doctora en Filología Románica, posee una habilitación en Traductología Aplicada y Didáctica de la Traducción, y es catedrática emérita de Traductología. A partir de 1967, ha sido docente de teoría y práctica de la traducción en las universidades de Heidelberg, Viena, Hildesheim, Innsbruck y Magdeburgo (1996-2005). Ha sido profesora visitante en muchos países de Europa, Próximo Oriente, América, Asia y África. Ha escrito cerca de doscientas publicaciones sobre los aspectos teóricos, metodológicos y didácticos del funcionalismo traductológico. Desde 2007, es profesora extraordinaria de la Universidad del Estado Libre en Bloemfontein (República de Sudáfrica). Obtuvo la licenciatura en Traducción (español-inglés) en la Escuela Universitaria de Traducción e Interpretación de la Universidad de Heidelberg, en 1967. En 1983, se doctoró en Estudios Románicos (Lengua y Literatura Española) y Traductología en la Facultad de Filología Moderna de la Universidad de Heidelberg, y en 1992 recibió la habilitación en Traductología Aplicada y Didáctica de la Traducción de la Universidad de Viena.

Yves Champollion:
«Si el texto fuente presenta una incoherencia semántica evidente, el humano la observa. La computadora la traduce»
El conocido traductor francés Yves Champollion sostuvo en esta entrevista que los traductores automáticos están muy desarrollados, pero no pueden explicar la experiencia humana. Agregó que el progreso técnico genera paradojas de acceso a un mar de información, situaciones de bajos salarios y también buenas oportunidades laborales.
¿Cuáles son las características que tiene o debería tener un traductor del siglo xxi frente, por ejemplo, a los traductores automáticos, que cada vez son más precisos?
El traductor del siglo xxi debe mantener un nivel de cultura elevado, que le permita comprender en profundidad el texto fuente y analizar rápidamente la pretraducción automática, para detectar las faltas y los contrasentidos. En el siglo xx, las industrias tradicionales creaban mucha terminología. Actualmente, las tecnologías de punta en materia de salud y de tecnologías de la información son las que más contribuyen a los diccionarios de las lenguas. La generación joven adopta con mucha rapidez la nueva terminología, mayormente anglosajona. Las Academias de cada país se ven forzadas a tomarlo en consideración, les guste o no. Así es el mundo.
Biografía de Yves Champollion

Yves Champollion nació en 1956 en París (Francia). Está emparentado con el egiptólogo francés de principios del siglo xix Jean-François Champollion, cuyas contribuciones a la traducción de los jeroglíficos egipcios fueron fundamentales para el desciframiento de la piedra de Rosetta.
Yves trabajó como traductor independiente entre 1982 y 1995, cuando tradujo y publicó las versiones francesas de varios libros de divulgación científica que fueron éxitos de ventas en Estados Unidos, como Darwin On Trial, de P. E. Johnson. De 1996 a 1999, fue gestor de proyectos y consultor de grandes proyectos de traducción en agencias de traducción internacionales, lo que lo llevó a participar en proyectos para SAP R/3 y R/4, Siemens, Alcatel, Microsoft, IBM, ABB y Ford, entre otros.
A partir del año 2000, desarrolló el conjunto de herramientas de traducción asistida por computadora Wordfast y PlusTools.
Habla francés, alemán, inglés, latín, español, portugués, ruso y algo de japonés.
| REVISTA CTPCBA | N.° 157 | ABRIL-JULIO 30 NOTICIAS DEL VII CONGRESO VII Congreso Latinoamericano de Traducción e Interpretación
El pensamiento vivo de los protagonistas del VII Congreso
Adolfo García:
Adolfo García, experto en neurolingüística y bilingüismo y director del Centro de Neurociencias Cognitivas de la Universidad de San Andrés, explicó qué actividades despliega el cerebro en el momento de la interpretación. Distinguió las diferencias entre monolingües y bilingües o multilingües, y explicó cómo funcionan las habilidades cognitivas a la hora de escuchar, comprender y traducir al mismo tiempo. También nos habló de formas novedosas para detectar patologías neurológicas.
Tenemos la interpretación consecutiva o simultánea. ¿Qué zonas del cerebro se activan en cada una de estas tareas?
El impacto de la experiencia de interpretación simultánea es tal que ni siquiera hay que esperar quince años de profesión para desarrollarla... ni diez... ni cinco. Hay estudios que muestran que después de unos meses de entrenamiento en interpretación simultánea ya surgen ventajas en la memoria operativa, se empieza a fortalecer ese sistema. Estos efectos son muy rápidos en su aparición. Se trata de un campo que está creciendo mucho y nos dice cosas sobre algo más general de nuestra condición humana, que es que nosotros somos los escultores
Chelo Vargas Sierra:
«Si las mujeres y los hombres somos iguales, debemos demostrarlo en nuestro lenguaje especializado, en la terminología utilizada y en los recursos lingüísticos que producimos»
Doctora en Traducción e Interpretación (inglés) y profesora del Departamento de Filología Inglesa de la Universidad de Alicante, Chelo Vargas Sierra nos brindó detalles de la ponencia que presentará en el VII Congreso, titulada «Terminología sensible al género. Visibilizando los problemas de salud de las mujeres a través del proyecto DIGITENDER y la colección WHealth».

¿Cuáles son los objetivos profesionales y sociales de DIGITENDER?
Hace algún tiempo empezamos a trabajar sobre recursos terminológicos relacionados con la salud de las mujeres, y de ahí que tengamos glosarios multilingües sobre menopausia, osteoporosis, cáncer de mama, de cuello de útero, etcétera. DIGITENDER nace con la determinación de visualizar a las mujeres a través de recursos terminológicos que versen sobre temas de salud relacionados con ellas y sobre patologías que, por su prevalencia o por sus características distintas a las de los hombres, son relevantes de ser estudiadas en las mujeres. Todos estos recursos que vayamos produciendo los publicaremos
de nuestro cerebro. Las cosas que hacemos en el día a día, sostenidamente, no son solo una manifestación de lo que nuestro cerebro nos da. Hay un ida y vuelta entre lo que el cerebro nos da y lo que hacemos con él. Y las cosas que hacés sostenidamente en el tiempo le brindan una coloratura particular a tu cerebro. La interpretación, en este sentido, es un caso testigo de lo que somos como especie: somos un vaivén constante entre nuestra biología y nuestra experiencia.
Biografía de Adolfo García

Adolfo García es director del Centro de Neurociencias Cognitivas de la Universidad de San Andrés, Senior Atlantic Fellow del Global Brain Health Institute (Universidad de California, San Francisco), investigador asociado de la Universidad de Santiago de Chile e investigador del CONICET. También es presidente de la red temática internacional TREC (Translation, Research, Empiricism, Cognition). Sus más de doscientas publicaciones versan principalmente sobre neurolingüística y bilingüismo. Su labor ha sido premiada por instituciones como la Linguistic Association of Canada and the United States, la Asociación Argentina de Ciencias del Comportamiento, la Legislatura de la Ciudad Autónoma de Buenos Aires y la Alzheimer’s Association.
en la web, en un formato que sigue los principios FAIR, esto es, serán encontrables, accesibles, interoperables y reutilizables.
Biografía de Chelo Vargas Sierra
Chelo Vargas Sierra es doctora en Traducción e Interpretación (inglés) y premio extraordinario de doctorado. Asimismo, es máster en Terminología (Instituto de Lingüística Aplicada [IULA], Universitat Pompeu Fabra, 2009) y en Traducción Audiovisual, Localización, Subtitulación y Doblaje (Universidad de Cádiz, 2017). Es profesora titular del Departamento de Filología Inglesa de la Universidad de Alicante por habilitación nacional y miembro fundadora y actual directora del Instituto Interuniversitario de Lenguas Modernas Aplicadas (IULMA). Ha dictado conferencias en España (Salamanca, Murcia, Sevilla, Cádiz, Valencia), en la sede de la Unión Europea (Bruselas y Luxemburgo), en Coventry (Gran Bretaña), Salzburgo (Austria), Colombia, Costa Rica, Perú y la Argentina. Es miembro del comité de redacción de revistas de carácter internacional (Ibérica, Sendebar, Revista de Lingüística y Lenguas Aplicadas, etc.) y ha participado como investigadora en varios proyectos de I+D+i (la mayoría de temática terminológica) financiados en convocatorias competitivas del plan nacional.
31 REVISTA CTPCBA | N.° 157 | ABRIL-JULIO |
«El lenguaje es un vehículo para acceder a nuestra experiencia»
Fernando Navarro:
«El objetivo primordial de mi labor divulgadora busca ser un canto vitalista a la deslumbrante belleza del lenguaje especializado de la medicina»
Fernando Navarro, traductor especializado en el lenguaje médico, contó en esta entrevista cómo desarrolló diccionarios, glosarios y bases de datos, y cómo, además, combinó su trabajo con la medicina gráfica. Entre otras grandes iniciativas, creó Cosnautas, una plataforma orientada a cubrir las necesidades documentales de los traductores, intérpretes, redactores y correctores de textos médicos.
¿Cuánto modificó e hizo crecer el campo de la traducción médica la aparición y expansión global de la COVID-19?

Muy al comienzo de la pandemia, el primer manual clínico sobre la COVID-19 se publicó en febrero de 2020, antes de que se describieran los primeros casos de transmisión local del coronavirus en Italia, en España, en los Estados Unidos. Y ese manual, escrito en chino, hubo de traducirse a decenas de lenguas en menos de un mes. Gracias a ello, cuando a España llegó la primera ola de la pandemia —la más mortífera de todas, con mucho—, los médicos de atención primaria en los centros de salud del ámbito rural pudieron leer en su propia lengua las primeras recomendaciones de prevención y tratamiento ante una enfermedad desconocida. Otro ejemplo: la primera vacuna anticovídica registrada en el mundo, el 11 de agosto de 2020, muchos meses antes que la alemana de Pfizer-BioNTech, fue la vacuna desarrollada por el Instituto Gamaleya de Moscú; pero sus resultados se publicaron inicialmente en ruso, por lo que en España pasó inadvertida para la prensa general durante más de medio año. Hubo que esperar hasta febrero de 2021, tras

la publicación de un ensayo clínico en inglés en la revista The Lancet, para empezar a oír hablar de ella como si fuera una gran novedad.
Biografía de Fernando Navarro
Fernando Navarro es médico especialista en farmacología clínica y trabajó entre 1993 y 2002 como traductor médico en los Laboratorios Roche en Basilea (Suiza). En la actualidad, es traductor médico autónomo para laboratorios multinacionales y organismos internacionales del sector biosanitario, docente del máster en Traducción Médico-Sanitaria de la Universitat Jaume I (veinte ediciones), director del Curso de Traducción Médica UIMP Santander (diez ediciones) y coordinador del Laboratorio del lenguaje de Diario Médico (Madrid) desde 2006. Es socio de honor de la Asociación Española de Traductores, Correctores e Intérpretes (Asetrad), de Tremédica, de la Asociación Internacional de Profesionales de la Traducción y la Interpretación (AIPTI) y de la Unión de Correctores (UniCo); socio fundador de la plataforma Cosnautas; miembro cofundador de MedTrad y de Tremédica; cofundador y primer director de la revista Panace@ de medicina, lenguaje y traducción; académico correspondiente de la Academia Norteamericana de la Lengua Española (Nueva York) y de la Real Academia de Medicina de Salamanca; vocal de la Iniciativa MEDES (Medicina en Español); y socio numerario de la Asociación Española de Médicos Escritores desde 1999. Es autor del Diccionario de dudas y dificultades de traducción del inglés médico, Repertorio de siglas médicas en español, Medizin. Gran diccionario médico alemán-español, Medicina en español (seis volúmenes publicados), Parentescos insólitos del lenguaje, entre otros.

| REVISTA CTPCBA | N.° 157 | ABRIL-JULIO 32 NOTICIAS DEL VII CONGRESO VII Congreso Latinoamericano de Traducción e Interpretación
El pensamiento vivo de los protagonistas del VII Congreso
Experto y pionero en traducción audiovisual, el catedrático español Jorge Díaz-Cintas —residente en Londres— explicó en qué consiste la Certificación AVT Pro, las posibilidades de implementarla en nuestro país y las últimas novedades que hay en este campo laboral que salió favorecido por la pandemia.


¿Cuáles son los cambios que se están produciendo en el mercado que generan exigencias con los requisitos profesionales de los traductores?
Hoy en día, la industria de la traducción audiovisual está en auge y hay nuevas necesidades que nos han pillado un poco desprevenidos. Por ejemplo, muchas empresas se quejan de que no encuentran gente preparada para trabajar como gestores de proyectos audiovisuales. Por otro lado, la traducción automática está haciendo su entrada en este campo y son pocos, por no decir ninguno, los centros educativos que tienen la posedición de subtítulos como parte de su oferta educativa. Y lo mismo se puede decir sobre la falta de profesionales preparados para crear plantillas de subtitulado y de doblaje que sean operativas y contengan las anotaciones necesarias para ayudar verdaderamente a los traductores. El otro gran cambio que hemos observado en años recientes es que el inglés ya no es la lengua por excelencia de los programas audiovisuales y, hoy en día, obras en español,

coreano, francés o alemán, por nombrar tan solo algunas lenguas, están teniendo una muy buena recepción en el mundo entero. Obviamente, esta mayor diversidad lingüística da lugar a situaciones hasta ahora poco comunes en la industria, como, por ejemplo, tener que traducir de un idioma poco conocido, como el coreano, a una multitud de lenguas en las que es difícil encontrar nativos con conocimientos sólidos de la lengua de partida. La solución que se viene aplicando es el uso del inglés como lengua bisagra, que no deja de ser una especie de mal menor.
Biografía de Jorge Díaz-Cintas
Jorge Díaz-Cintas es catedrático de Traducción y fundador del Centre for Translation Studies (CenTraS) en University College London. Es autor de numerosos artículos y libros centrados en la traducción audiovisual, incluido Subtitling: Concepts and Practices (con Aline Remael, 2021). Pionero en traducción audiovisual, Jorge ha formado traductores en todo el mundo, ha sido ponente invitado en numerosos congresos internacionales y ha ofrecido sus servicios como consultor a instituciones y empresas como el Parlamento Europeo, la Comisión Europea, la OTAN, OOONA, Deluxe y Netflix, entre otros. Es editor en jefe de la serie New Trends in Translation Studies y ha recibido los premios Jan Ivarsson Award (ESIST, 2014) y Xènia Martínez (ATRAE, 2015) por sus servicios en el campo de la traducción audiovisual.
33 REVISTA CTPCBA | N.° 157 | ABRIL-JULIO |
Jorge Díaz-Cintas:
«La industria de la traducción audiovisual ha vivido, y sigue viviendo, una época dorada»

| REVISTA CTPCBA | N.° 157 | ABRIL-JULIO 34
Desde 1998, Traduarte es un espacio propio que identifica a los traductores matriculados que tienen iniciativas artísticas.
La muestra es abierta, y se puede presentar todo tipo de obras (pinturas, fotografías, esculturas, dibujos, entre otras). En definitiva, toda aquella obra de arte realizada por un traductor, que no solo traduce.

Por eso, anunciamos con mucho entusiasmo que este año realizaremos la edición 2023.
Próximamente, brindaremos más información con las bases para participar y la fecha de inauguración, por medio de las redes sociales, el sitio web y la gacetilla institucional.
Ryukichi Terao: traducción del japonés al español y del español al japonés
Los lectores de lengua y literatura japonesa y de la obra de Jorge Luis Borges pudieron disfrutar de una conferencia del profesor de la Universidad de Waseda (Japón) Ryukichi Terao, notable hispanista que traduce del japonés al español y del español al japonés. Experto en la obra de los escritores Ryūnosuke Akutagawa y Junichirō Tanizaki, sedujo al público congregado en el auditorio Tsugimaru Tanoue con su conocimiento de la obra del más grande escritor argentino.
Introducción
Todo surgió cuando supimos que Ryukichi Terao vendría a Buenos Aires y disertaría sobre la importancia de la traducción, un tema de mucho interés y en un año en que se conmemora el 125.º aniversario del establecimiento de relaciones diplomáticas entre Japón y la Argentina.
Supimos que el Centro Cultural e Informativo de la Embajada del Japón era el organizador de las actividades del doctor Terao en la Argentina y, al mismo tiempo, sería el coorganizador junto con el CTPCBA, el Centro de Estudios de Asia y África de la Facultad de Filosofía y Letras de la Universidad Nacional de Tucumán, el Museo MALBA y el Instituto Tōzai, Fundación Internacional Tōzai (Oriente y Occidente).
Entonces, nos comunicamos con la traductora pública Beatriz Rodriguez, presidenta del CTPCBA, para consultarle su opinión acerca de la importancia de realizar una de las conferencias en el lugar por excelencia de la traducción: el Colegio de Traductores Públicos de la Ciudad de Buenos Aires.
Por otra parte, relacionamos el valor de esta actividad, ya que la lengua japonesa está presente, oficialmente, en el CTPCBA y en la carrera de Traductor Público en la Facultad de Derecho de la Universidad de Buenos Aires.
Nos parecía una muy buena oportunidad para poder escuchar a este importante hispanista, que traduce directamente del japonés al español y del español al japonés. La traductora Rodriguez confió en la importancia de la actividad y, así, la conferencia se realizó el 20 de marzo de 2023, en forma presencial, en el auditorio Tsugimaru Tanoue, y también en forma virtual. Dicha
actividad estuvo coordinada por la Comisión de Idiomas de Baja Difusión y la Comisión de Traducción Literaria y Editorial.
La disertación fue sobre «Ryūnosuke Akutagawa1, fantaseado por Jorge Luis Borges: una lectura comparada». Se trató de una lectura comparada del cuento «Sennin», enfocada en la traducción fantasiosa de Jorge Luis Borges y la nueva traducción, directa del japonés, del mismo cuento, por Ryukichi Terao.
Antes de explicar el contenido de la disertación, nos gustaría mencionar que Ryukichi Terao es profesor en la Universidad de Waseda —una de las universidades privadas más importantes y prestigiosas de Japón—, traductor especialista en literatura española e hispanoamericana y doctor en Letras por la Universidad de Tokio2. Es importante señalar, también, que otra de sus disertaciones en la Argentina fue «Junichirō Tanizaki3 en la literatura argentina: en torno a la estética de El elogio de la sombra», realizada en el Museo MALBA el 18 de marzo, donde el doctor Terao dio una clase magistral y se expresó sobre la importancia del valor cultural en la nueva traducción directa del japonés.
1 Ryūnosuke Akutagawa (Tokio, 1892-1927) es considerado el «padre de los cuentos japoneses». Por este motivo, en su honor, se estableció el Premio Akutagawa, el galardón literario más prestigioso de Japón. Se quitó la vida a los 35 años de edad.
2 La Universidad de Tokio (Tōkyō Daigaku) entre los años 1886 y 1947 se denominaba Universidad Imperial de Tokio. Es considerada la universidad más prestigiosa de Japón y una de las más prestigiosas del mundo.
3 Junichirō Tanizaki (Tokio, 1886-Kanagawa, 1965), importante escritor japonés, recibió la Orden de la Cultura por el Gobierno japonés (1949). También fue elegido miembro honorario por la Academia Estadounidense de las Artes y las Letras.
| REVISTA CTPCBA | N.° 157 | ABRIL-JULIO 36 COMISIONES DEL COLEGIO Comisión de Idiomas de Baja Difusión y Comisión de Traducción Literaria y Editorial
| Por la doctora Stella Maris Acuña
Aparición del cuento «Sennin» en una antología de la literatura fantástica
El doctor Terao tomó, para su disertación, el cuento «Sennin», nombre con el cual se lo conoce en la Argentina. Como él mencionó, el cuento fue incluido con ese nombre en el libro Antología de la literatura fantástica, compilado por Adolfo Bioy Casares, Jorge Luis Borges y Silvina Ocampo. En 1940, cuando apareció la primera edición de dicha antología, no estaba incluido; más adelante, sus compiladores lo incluirían en la publicación de 1965
Es interesante también observar que los prólogos a la edición de 1940 y de 1965 fueron escritos por Bioy Casares. Y otro dato relevante es que en la versión de 1965 aparece en el texto a manera de prólogo y bajo el título «Posdata» el nombre del autor, Akutagawa, escrito como Acutagawa. En el final del prólogo de esta edición, versa lo siguiente: «A. B. C., Rincón Viejo, Pardo, 16 de marzo de 1965».
En el cuento «Sennin», de la antología, en la nota al pie de página, se expresa la siguiente aclaración: «Según la tradición china, el Sennin es un ermitaño sagrado que vive en el corazón de una montaña, y que tiene poderes mágicos, como el de volar cuando quiere y disfrutar de una extrema longevidad».
Ahora, se hace necesario aclarar algún aspecto sobre el significado del vocablo Sennin. Escrito en kanji o ideograma, se representa con los grafemas /sen-nin/ 仙人; esta palabra está compuesta de los ideogramas /sen-/ 仙, que es un morfema compuesto, representado por dos morfemas raíces: el de la izquierda significa ‘persona’ y el que está a la derecha, ‘montaña’; y, por último, el grafema /-nin/ 人, que es otro morfema raíz, cuya semántica es ‘persona’.
Quisimos hacer esta aclaración porque en el Diccionario japonés-español (1999) se muestra una sola acepción: ‘ermitaño’. Y en el diccionario electrónico Ex-word de Casio se presentan dos acepciones: ‘ermitaño’ y ‘anacoreta’.

Con respecto a la traducción del vocablo, el doctor Terao comentó que, en su versión del japonés al español del cuento en cuestión, lo interpreta y lo publica con el nombre de «El mago»4.

Traducción del inglés del cuento «Sennin», por Borges Sin entrar en aclaraciones sobre el momento en que el traductor interpreta y traduce, queremos expresar que no solo se aplican los conocimientos lingüísticos y extralingüísticos en un trabajo de interpretación y traducción, sino que también hay otros elementos de importancia, como por ejemplo, la cultura de la lengua de llegada, entre otros.
¿Qué ocurre cuando en pleno trabajo de traducción hay una ausencia de palabra que corresponda a las palabras de otra lengua? ¿Y si hubiera más de una palabra?
37 REVISTA CTPCBA | N.° 157 | ABRIL-JULIO |
4 El mago. Trece cuentos japoneses (2012), traducción directa del japonés Ryukichi Terao, con la colaboración en la traducción y prólogo de Ednodio Quinteros (editorial Candaya).
Observemos la siguiente cita:
El vacío léxico existe realmente pero plantea problemas en la práctica solo cuando hay términos que designan en una lengua objetos o costumbres que no existen en la civilización de llegada; se trata entonces de diferencias culturales
El conjunto de la extensión semántica de una palabra, al no poder encontrarse en la traducción perdería algo del original... (Lederer, 2017, p. 71)
Ahora bien, ¿cómo se inicia el cuento en la traducción del inglés realizada por Borges e incluida en la Antología de la literatura fantástica?
Para sorpresa de quienes escuchábamos atentamente al hispanista Terao, nos enteramos de que el cuento de Akutagawa en el original en japonés, traducido por Terao, comienza del siguiente modo: «Señores y señoras: como ahora estoy en Osaka, contaré una historia de esta ciudad».
Y el cuento traducido del inglés por Borges comienza así: «Un hombre que quería emplearse como sirviente llegó una vez a la ciudad de Osaka».
Esto quiere decir que en la traducción del inglés al español no estaba el inicio del cuento original en japonés. En una entrevista que le hicieron a Terao (Quiring, 2014), una de las preguntas fue sobre Borges y sobre lo que pensaba este escritor con respecto a la traducción:
—Jorge Luis Borges aseguraba que traducir implicaba crear otra obra.
—Borges, de hecho, creaba una nueva obra. Cambiaba el final. Hay un cuento de un autor japonés —«Sennin», de Ryūnosuke Akutagawa—, recopilado en Antología de la literatura fantástica, cuyo final está cambiado en su totalidad. Lo tradujimos al español, así que ahora ustedes pueden contrastar dos cuentos absolutamente diferentes.
Una vez concluida la conferencia en el CTPCBA, en el momento de las preguntas, una asistente mencionó que el inicio del relato, en la lengua original, revela un cuento enmarcado. Pero, entonces, ¿qué ocurre cuando le sacamos el marco? Sobre todo, si pensamos que el marco, en un cuento, es una técnica literaria. Y a pesar de que la narración enmarcada tiene una duración breve, por ejemplo, en el inicio, desde el punto de vista estilístico es muy importante.
Entendemos que el proceso de traducción tiene fases: una es la de la comprensión de lo previamente expresado en el texto original, la otra es la de la expresión de lo comprendido en un nuevo texto formado en la lengua terminal (García Yebra, 2006, p. 10).
¿Se puede entonces omitir palabras o frases de un texto original?
Por lo general, se trata de que en la lengua de llegada se pueda mantener la esencia de la obra de partida. En una traducción se hace no solo una reproducción del contenido, sino que también se respeta su estilo, en la medida de lo posible (García Yebra, 2006, p. 12).
Conclusiones
Hemos tratado de comentar, en forma breve, la conferencia del doctor Ryukichi Terao sobre el tema de la traducción, tomando como ejemplo el cuento «Sennin», de Ryūnosuke Akutagawa.
Expresamos algunas cuestiones sobre la traducción desde la lengua original, el japonés, y también desde el inglés hacia el español, la lengua terminal.
Nos encontramos con algunas cuestiones para tener en cuenta. ¿Puede el traductor omitir palabras o frases del texto original en la lengua de llegada? ¿Cuál sería el motivo? ¿Se justifica?
El conferencista manifestó que él, en una traducción, no podría modificar un texto original. Y con mucho respeto, hablando sobre la traducción de Borges, comentó que, a


| REVISTA CTPCBA | N.° 157 | ABRIL-JULIO 38
COMISIONES
DEL COLEGIO Comisión de Idiomas de Baja Difusión y Comisión de Traducción Literaria y Editorial
Ryukichi Terao: traducción del japonés al español y del español al japonés
pesar de que faltaba el inicio del relato, en su traducción del inglés al español, por lo menos, en la Argentina, se pudo conocer ese texto de Akutagawa. No tuvo reproches para hacer, solo comprensión.
Resaltaremos algunos aspectos mencionados por el doctor Terao durante la conferencia y que tomamos para esta conclusión.

Expresó que, a la hora de traducir, la esencia de la obra debe conservarse y que, en una buena traducción literaria, se puede preservar su espíritu.
Lo que sigue es una de las afirmaciones que hablan de la libertad del traductor. Dijo: «Solo traduzco obras que me gustan y autores que admiro». Aquí, no solo habla de la libertad que envuelve el trabajo de un traductor, sino también de aplicar en este menester la mente, el corazón y el alma.
Creemos que esto último es lo que marca el camino, que simplemente es la vía de la verdad.
Bibliografía
Bioy Casares, A., Borges, J. L. y Ocampo, S. (1971). Antología de la literatura fantástica (4.ª ed.). Sudamericana.
García Rojas, E. (30 de septiembre de 2019). Ryukichi Terao: «Tengo pesadillas cuando traduzco al japonés un libro de Carpentier». El Escobillón https://www.elescobillon.com/2019/09/ ryukichi-terao-“tengo-pesadillas-cuando traduzco-al-japones-un-libro-de-carpentier”/
García Yebra, V. (2006). Experiencias de un traductor. Gredos.
Lederer, M. (2017). La traducción. El modelo interpretativo (B. Rodriguez, trad.). Eudeba. Trabajo original de 1994.
Maillot, J. (1997). La traducción científica y técnica. Gredos.
Miyagi, N. y Contreras, E. (dirs.). (1999). Diccionario japonés-español. Hakusuisha.
Peña Pupo, E. (18 de julio de 2021). Ryukichi Terao y el boom latinoamericano al japonés. Medium. https://medium.com/el-caiman-barbudo/ryukichi-terao-y-el-boom-latinoamericano-al-japon-e517a6ee464e
Quiring, D. (26 de noviembre de 2014). «La escuela del símbolo». La Diaria. https://ladiaria.com.uy/ articulo/2014/11/la-escuela-del-simbolo/
Scherer, F. (20 de noviembre de 2014). Ryukichi Terao: «Del japonés al español no existe traducción literal; es imposible». La Nación. https://www. lanacion.com.ar/cultura/ryukichi-terao-del-japones-al-espanol-no-existe-traduccion-literal-es-imposible-nid1745383/
Solodovsky, M. (16 de marzo de 2023). Terao Ryukichi, el desafío de la literatura en español. XIAHPOP https://xiahpop.com/terao-ryukichi-especialista-en-literatura-latinoamericana/
Anexo
Sobre Ryukichi Terao
Durante su disertación en el CTPCBA, con su presencia y su palabra, el importante hispanista y traductor doctor Ryukichi Terao nos ha mostrado claramente el buen uso de la lengua española y, al mismo tiempo, su correcta articulación en el manejo de los fonemas durante el acto de habla. Asimismo, el respeto que siente en cada interpretación y traducción en la cual trabaja.
En noviembre de 2014 también estuvo en la Argentina y se llevó a cabo un «Diálogo con el profesor Ryukichi Terao en la Biblioteca Nacional Mariano Moreno», organizado por el Centro Cultural de la Embajada del Japón en la Argentina.

39 REVISTA CTPCBA | N.° 157 | ABRIL-JULIO |
Trabaja en la Facultad de Ciencias Sociales de la Universidad de Waseda, en Tokio (Japón). Tiene a cargo las siguientes cátedras: Estudios Culturales Latinoamericanos, Lengua Española, Sociedad y Cultura en el Mundo Hispanoparlante, Cultura y Sociedad en el Mundo Hispanoparlante y Lectura en Español.
Obras traducidas del japonés al español
2007: Junichirō Tanizaki, Ningen ga saru ni natta hanashi (Historia de la mujer convertida en mono. Siete cuentos japoneses), Caracas, Bid&Co.
2009: Junichirō Tanizaki, Jotaro (Jotaro el masoquista), Caracas, Bid&Co.
2010: Kōbō Abe, Ningen sokkuri (Idéntico al ser humano), Barcelona, Candaya.
2011: Kōbō Abe, Tanpenshu (Los cuentos siniestros), Buenos Aires, Eterna Cadencia.
2011: Junichirō Tanizaki, Neko to Shozo to futari no onna (La gata, Shozo y sus dos mujeres), Madrid, Siruela.
2012: Kōbō Abe, Hako-otoko (El hombre caja), Madrid, Siruela.
2012: Kenzaburō Ōe, Sayonara, watashi no hon yo (¡Adiós, libros míos!), Barcelona, Seix Barral.

2012: Ryūnosuke Akutagawa, Tanpenshu (El mago. Trece cuentos japoneses), Barcelona, Candaya.
2013: Kōbō Abe, SF sakuhinshu (Historia de las pulgas que viajaron a la Luna), Buenos Aires, Eterna Cadencia.
2014: Kenzaburō Ōe, Suishi (Muerte por agua), Barcelona, Seix Barral.
2014: Kōbō Abe, Mikkai (Encuentros secretos), Buenos Aires, Eterna Cadencia.
2015: Kōbō Abe, Moetsukita chizu (El mapa calcinado), Buenos Aires, Eterna Cadencia.
2016: Kenzaburō Ōe, Utsukushii Annabel Lee (La bella Annabel Lee), Barcelona, Seix Barral.
2017: Junichirō Tanizaki, Tanpenshu (Siete cuentos japoneses), Madrid, Atalanta.
2018: Kōbō Abe, Akai mayu (Capullo rojo), México, Fondo de Cultura Económica.
2022: Junichirō Tanizaki, Akuma sonota no tanpenshu (El demonio y otros cuentos), Gijón, Satori.
Traducciones del español al japonés
Desde 2009 y hasta la actualidad, ha traducido del español al japonés obras de los siguientes autores: Horacio Castellanos Moya, Ernesto Sabato, Juan Gelman, Juan Carlos Onetti, Sergio Ramírez, Juan José Saer, Guillermo Cabrera Infante, Julio Cortázar, José Donoso, Carlos Fuentes, Gonzalo Rojas, Rómulo Gallegos, Mario Levrero, Mario Vargas Llosa.
En 2022 se publicó la traducción de la obra de Silvina Ocampo, Cuentos completos I y Cuentos completos II, cuya edición está agotada.
Actualmente, está traduciendo a Macedonio Fernández.
Agradecemos al Centro Cultural e Informativo de la Embajada del Japón, por el material de consulta ofrecido para este artículo.
| REVISTA CTPCBA | N.° 157 | ABRIL-JULIO 40
COMISIONES DEL COLEGIO Comisión de Idiomas de Baja Difusión y Comisión de Traducción Literaria y Editorial
Ryukichi Terao: traducción del japonés al español y del español al japonés
Terminología técnico-científica y sus curiosidades: cellulite o cellulitis
| Por la traductora pública Valeria Marina Bono, coordinadora de la Comisión de Área Temática Técnico-Científica
Los términos cellulite y cellulitis, claramente distintos en inglés, presentan la singular dificultad de que en español se expresan, generalmente, con la misma palabra: celulitis. Entonces, ¿cuál es la diferencia?
En primer lugar, cellulite es una afección muy común e inofensiva en la que la piel tiene un aspecto abultado debido a la alteración de los depósitos grasos subcutáneos. Este efecto es fundamentalmente cosmético y se presenta, en mayor medida, en el abdomen, los muslos y los glúteos. Se la conoce coloquialmente como piel de naranja
Por otro lado, el término cellulitis se refiere a una infección cutánea bacteriana potencialmente seria. Se produce cuando las bacterias penetran en la piel tras un corte, una quemadura, una úlcera, una herida punzante o incluso una incisión quirúrgica. A medida que las bacterias aumentan, las células del cuerpo empiezan a luchar contra la infección, lo que puede provocar inflamación, enrojecimiento, dolor y sensación de calor al tacto. Puede producirse en cualquier parte del cuerpo, pero es más frecuente en la parte inferior de la pierna.

En caso de encontrarnos con estos términos en textos en los que podría existir ambigüedad, puede ser recomendable recurrir a nombres más descriptivos para evitar cualquier confusión. Así, cellulite podría traducirse al español como celulitis estética o celulitis cosmética, o incluso como piel de naranja, siempre que el registro y el público destinatario del texto lo admitan, mientras que cellulitis podría traducirse como celulitis infecciosa o celulitis bacteriana.
Fuentes de consulta:
https://www.mayoclinic.org/diseases-conditions/ cellulitis/symptoms-causes/syc-20370762
https://www.mayoclinic.org/diseases-conditions/ cellulite/symptoms-causes/syc-20354945
https://www.medicinenet.com/difference_between_ cellulite_and_cellulitis/article.htm
41 REVISTA CTPCBA | N.° 157 | ABRIL-JULIO | COMISIONES DEL COLEGIO Comisión de Área Temática Técnico-Científica
La investigadora Andrea Bohrn dio una conferencia en el CTPCBA, en la que explicó cómo y por qué el lunfardo subsiste, se transforma y «se encuentra en el español que respiramos todos los días». También sostuvo que el lunfardo no se debe pensar como una deformación o una corrupción del idioma, «pertenece a todos los estratos sociales y puede marcar un posicionamiento».
| Por el traductor público Maximiliano Cuadrado, integrante de la Comisión de Idioma Español
El miércoles 9 de noviembre de 2022, la Comisión de Idioma Español del Colegio organizó la actividad titulada «Lunfardo: recursos de formación de palabras contemporáneos», mediante videoconferencia. La actividad estuvo a cargo de Andrea Bohrn, licenciada y profesora en Letras por la Universidad de Buenos Aires, profesora de la asignatura Lunfardo en la Universidad Nacional de la Artes y de las asignaturas Estudios Gramaticales y Sintaxis y Variación Lingüística en la Universidad Nacional de General Sarmiento, y miembro de la Academia Porteña del Lunfardo, en la cual actualmente ocupa el sillón Roberto Arlt.
La oradora nos habló de cómo el lunfardo subsiste en la actualidad, cambia con el paso del tiempo y se encuentra en el español que respiramos todos los días, y citó a Oscar Conde, miembro destacado de la Academia, quien define al lunfardo como «el repertorio léxico, limitado a la región rioplatense en su origen, constituido por términos y expresiones populares de diversa procedencia utilizados en
alternancia o abierta oposición a los del español estándar y difundido transversalmente en todas las capas sociales de la Argentina».
Andrea nos explicó que el lunfardo no se debe pensar como una deformación o una corrupción del idioma; este pertenece a todos los estratos sociales y puede marcar un posicionamiento. Mencionó como ejemplo de esto que, cuando alguien dice yuta o botón en vez de decir policía, implica que no considera al policía dentro de su mismo grupo de pertenencia.
Andrea destacó cuál es el funcionamiento de la gramática detrás del lunfardo, que puede formarse de estas maneras:
― Con recursos no concatenativos, es decir: mediante la inversión del orden de las sílabas de la palabra para expresar un matiz lúdico y apreciativo, llamado el vesre, como por ejemplo, al decir feca en vez de café o lleca/yeca en vez de calle; mediante la paronomasia, es decir, la asociación de dos palabras a partir de una similitud fonológica, donde una de ellas aporta la forma fonética y la otra el significado: todo viento; mediante el cruce léxico, que es la
| REVISTA CTPCBA | N.° 157 | ABRIL-JULIO 42 COMISIONES DEL COLEGIO Comisión de Idioma Español
combinación de dos fragmentos de palabras en una nueva unidad, con un fin lúdico-festivo, por ejemplo, gato + hijo = gatijo.

― Con recursos concatenativos, es decir: mediante el uso de los formantes -o(v)ski: No pusiste una fotoski en el aviso,

población de ingreso a la Argentina provenía de varios países de ese continente, así como de las lenguas de los pueblos originarios y las africanas.

-eli: ¿No es medio careli el café a ese precio?, -acho: Mi querido amigacho

Con respecto a los requisitos para que exista un lunfardismo, Andrea destacó la importancia de que los términos o expresiones perduren en el tiempo, no queden asociados solamente a un sector, ya que es necesario que lleguen a todas las capas sociales, y sean privativos de la Argentina. Si ellos carecieran de valor apreciativo, no serían lunfardismos; por ejemplo, si simplemente mencionáramos un término como capuchino, no sería lunfardismo.
o -ng-: Una birringa en la calle.

La actividad finalizó con un espacio para realizarle preguntas a la oradora.
La oradora, asimismo, destacó que Mario Egidio Teruggi (1979) reconoce tres períodos del lunfardo: el primero es el desarrollo, de 1865 a 1918; el segundo es la asimilación, comprendida entre los años 1918 y 1950; y el tercero es el rebrote, entre los años 1950 y 1979. El lunfardo se nutrió de distintas lenguas de Europa, puesto que gran parte de la
43 REVISTA CTPCBA | N.° 157 | ABRIL-JULIO |
El traductor público, el idioma nacional y la lengua materna: vulnerabilidad y derechos

La ausencia de un intérprete oficial en la instancia judicial de la legítima defensa se hace evidente y grave cuando un acusado no entiende la lengua en la cual se lo acusa de un delito, en este caso, el castellano. El autor de este exhaustivo artículo reflexiona acerca del papel del traductor público como garante del «ejercicio efectivo de los derechos de entender y ser entendido como un derecho humano inmanente». También demuestra cómo se violan derechos fundamentales al no designarse a los únicos profesionales capaces de garantizar la tutela judicial efectiva del derecho de entender y ser entendido que el Estado argentino debe cumplir y hacer cumplir. Y concluye: «Sin traductor público no hay derechos, sin derechos no hay justicia y sin justicia no hay Estado democrático de derecho».

Lo social, para los seres humanos, se constituye en el lenguaje. Todo fenómeno social es siempre un fenómeno lingüístico.
En publicaciones anteriores me referí a casos en los cuales el traductor público matriculado, actuando en calidad de auxiliar de la Justicia y no de mero perito, se constituyó en el único y verdadero garante de la tutela judicial efectiva de los derechos lingüísticos en el marco de un proceso penal; derechos que conforman un bloque de insoslayables garantías constitucionales establecidas no solo por los artículos 14, 16, 18, 19, 33 y 75 —incisos 17 y 22— de nuestra ley fundamental, sino además por los tratados de derechos humanos jerarquizados con idéntico estándar luego de la reforma de 1994.
Así, entre los fallos citados podemos recordar Vázquez Quiroga, Milciades Ramón y otro s/ Homicidio simple, con cita del voto
—lamentablemente, en minoría— de la entonces jueza María Laura Garrigós de Rébori (Cámara Nacional de Casación Penal en lo Criminal y Correccional de la Capital Federal, 28 de marzo de 2018).
En ese caso, no obstante los contundentes argumentos de la nombrada magistrada, la nulidad planteada por la defensa de Vázquez Quiroga respecto de la condena de su asistido a siete años de prisión, con fundamento en la falta de un intérprete del idioma guaraní —lengua del imputado—, no tuvo acogida favorable por parte de los otros dos jueces que integraron la Sala —García y Bruzzone— y que declararon la nulidad, pero basándose en otros motivos.
| REVISTA CTPCBA | N.° 157 | ABRIL-JULIO 44 Derechos y traducción EL MUNDO DE LA TRADUCCIÓN
| Por el traductor público Norberto Caputo, | vicepresidente del CTPCBA y responsable a cargo de la Comisión de Lenguas Originarias
R afael e cheve RR ía , Ontología del lenguaje
Esta vez, el análisis que propongo es en relación con otro fallo, en el marco de la Causa N.º 69.680, caratulada M. B., R. s/ Recurso de casación, resuelto con fecha 29 de diciembre de 2016.
El tribunal que intervino fue la Sala VI del Tribunal de Casación Penal de la Provincia de Buenos Aires, integrada por los señores jueces doctores Ricardo R. Maidana y Mario Eduardo Kohan.
Los antecedentes del caso eran realmente graves, puesto que se trataba de una condena a la «pena de prisión perpetua, accesorias legales y costas, por resultar coautora penalmente responsable de la comisión de los delitos de homicidio doblemente agravado por haber sido cometido con alevosía y para facilitar la comisión del delito de robo, en concurso real», sentencia dictada el 28 de octubre de 2014, contra Reyna Maraz Bejarano (R. M. B.), por el Tribunal Oral en lo Criminal N.º 1 del Departamento Judicial de Quilmes.
En resumen: condenaron a R. M. B. —ciudadana boliviana— por haber matado a su pareja mientras este dormía y por haberle robado una suma de dinero en poder de aquel, todo ello en complicidad con otra persona.
Contra ese pronunciamiento, la defensora oficial general interpuso recurso de casación que dio lugar a la intervención de la Sala VI.
De los argumentos de la defensa para impugnar la condena, a los fines de este análisis, quiero poner de relieve el que se refiere a la refutación del fundamento del Tribunal Oral según el cual R. M. B. incurrió en «mendacidad al afirmar no dominar el idioma castellano». También es relevante —por su compromiso idiomático— el que cuestiona la decisión del mismo tribunal en relación con la entidad otorgada a la declaración del menor de edad —quichuaparlante— hijo de la víctima y la imputada para sustentar la condena.
Admitido el recurso formalmente, el primer voto recayó en el juez Ricardo R. Maidana.
Antes de introducirse en la cuestión de fondo, el citado magistrado se pronunció sobre las condiciones personales de la imputada. Así, manifestó:
[Esas condiciones] la ubican dentro de los denominados «grupos vulnerables», siendo que esta pertenece a una comunidad indígena, es quechua parlante [...], víctima de violencia de género dentro del ámbito conyugal, analfabeta [...], y es inmigrante —con escasos recursos económicos— del Estado Plurinacional de Bolivia, lugar en donde habitaba en una comunidad cuyas diferencias estructurales, organizacionales y culturales son imposibles de obviar a los efectos de la presente.
Por esa razón, estimó: «[T]odo ello merece un tratamiento diferenciado y supone incorporar perspectivas específicas, tal como lo dispone la Constitución Nacional y la normativa de derechos humanos incorporada a nuestro ordenamiento jurídico interno».
En ese sentido, entendió necesario referirse a la contextualización sociocultural de R. M. B., puesto que consideró que ello no puede resultar un detalle menor, especialmente cuando se trata de una causa cuya pena impuesta ha sido de prisión perpetua.
En ese orden de ideas sostuvo que, conforme surge de las constancias del expediente, «la imputada es originaria del Estado Plurinacional de Bolivia, perteneciente al Pueblo Indígena Quechua cuya lengua lleva ese mismo nombre (kichwa), habiendo vivido la mayor parte de su vida en una zona rural cercana a un poblado llamado Avichuca», así como también que «vino a la Argentina, a Buenos Aires y luego a Florencio Varela, menos de un año antes de ocurrido el hecho en cuestión, junto a sus dos hijos K. y F., por decisión de su pareja L. S. V., quien ya vivía aquí».

45 REVISTA CTPCBA | N.° 157 | ABRIL-JULIO |
Derechos y traducción EL MUNDO DE LA TRADUCCIÓN
El traductor público, el idioma nacional y la lengua materna: vulnerabilidad y derechos
Y concluyó:
R. M. B. fue trasladada de una cultura diversa, con idiosincrasia, valores y forma de vida distintos a los occidentales predominantes en nuestra nación. Y, justamente, es en el entendimiento de la diversidad que el derecho debe actuar buscando la integración y compatibilización de sus normas al crisol y multiplicidad de culturas que habitan en la República Argentina
El juez sostuvo:
Las obligaciones internacionalmente asumidas por el estado argentino a través de la ratificación y jerarquización constitucional de ciertas normas del derecho internacional de los derechos humanos (art. 75 inc. 22), establecen la necesidad de cambios coyunturales en las leyes, pero también en la administración de justicia y sus operadores.
Y consideró:
[S]on especialmente aplicables a las particularidades de esta causa y tienen jerarquía constitucional los siguientes artículos: 2.1, 14 y 26 del PIDCP [Pacto Internacional de Derechos Civiles y Políticos]; 1.1 y 8 de la CADH/Convención Americana, y 1 y ss. de la ICERD [Convención Internacional sobre la Eliminación de Todas las Formas de Discriminación Racial, ONU, 1969. Ratificada por la República Argentina por Ley 17722, jerarquizada constitucionalmente en el artículo 75, inciso 22, de la Constitución nacional].
Partiendo de la definición del artículo primero de la ICERD, el magistrado sostuvo que «discriminar es también no contextualizar las circunstancias particulares de una determinada persona cuya concepción y formación sociocultural es totalmente diversa a la imperante en el ámbito que nos ocupa» De esto colige lo siguiente:
La falta de abordaje acerca de las circunstancias particulares de R. M. B. en el contexto de la administración de justicia en materia penal, han generado una clara discriminación hacia su persona que no hace más que sembrar de dudas la objetividad de la sentencia acerca de su culpabilidad frente al hecho en cuestión.
Citó jurisprudencia de la Corte Interamericana de Derechos Humanos (CIDH). Así, mencionó y analizó la causa López Álvarez vs. Honduras (sentencia del 1.º de febrero de 2006), caracterizada por la presencia de miembros de la comunidad garífuna como imputados.
En este caso, la CIDH señaló:
«[L]a lengua es uno de los más importantes elementos de identidad de un pueblo, precisamente porque garantiza la expresión, difusión y transmisión de su cultura», por lo que la limitación al
ejercicio de la libertad de hablar la lengua implica en muchos contextos, como el que nos compete, una restricción al ejercicio de la libertad de expresión, incompatible con la garantía prevista en la CADH, a la vez que constituye un acto discriminatorio contra la persona [...], frente a tal limitación, el Estado tuvo responsabilidad por la violación de los derechos a la libertad de pensamiento y de expresión, y de la igualdad ante la ley. [La negrita me pertenece].
Asimismo, citó el caso Rosendo Cantú y otra vs. México, ventilado en la Comisión de Derechos Humanos y referido a los obstáculos que enfrentan particularmente las mujeres indígenas para acceder a la justicia, generalmente relacionados con la exclusión social y la discriminación étnica (sentencia del 31 de agosto de 2010), al que comparó con la situación de la imputada R. M. B.
El magistrado afirmó que en este caso:
[L]a Corte IDH estableció que la imposibilidad de denunciar y recibir información en su idioma en los momentos iniciales puede implicar un trato que no tome en cuenta la situación de vulnerabilidad de la persona, basada en su idioma y etnicidad, resultando en un menoscabo de hecho injustificado al derecho de acceder a la justicia, lo que inevitablemente perjudica también el derecho de defensa. [La negrita me pertenece].
Asimismo, mencionó la causa Pueblo Indígena Kichwa de Sarayaku vs. Ecuador (CIDH, sentencia del 27 de junio de 2012), en la que se estableció que «el reconocimiento del derecho a la identidad cultural es ingrediente y vía de interpretación transversal para concebir, respetar y garantizar el goce y ejercicio de los derechos humanos de los pueblos y comunidades indígenas protegidos por la Convención».
Y específicamente con referencia a la República Argentina, citó al Comité de Derechos Humanos de la Organización de las Naciones Unidas en la causa LNP vs. Argentina, que involucró al Estado en el actuar discriminatorio y sin perspectiva social y cultural de la administración de justicia, al juzgar un hecho de abuso sexual.
En este caso:
[E]l Comité también consideró como una violación del estado al derecho de acceso a los tribunales en condiciones de igualdad, que el proceso fuera desarrollado íntegramente en español, idioma con el que los testigos, la víctima y los imputados tenían problemas de comunicación (Comité DDHH-ONU, 2011). [La negrita me pertenece].
| REVISTA CTPCBA | N.° 157 | ABRIL-JULIO 46
El juez de Casación expresó:
Similar a lo sucedido en las circunstancias de la presente causa, se puso fuertemente en duda la credibilidad de la niña —en el caso R. M. B.—, víctima de violencia sexual, a punto tal que, luego del análisis de la causa, el Comité emitió un dictamen en el que estableció que el Estado Argentino violó una serie de normativas internacionales, con jerarquía constitucional, y concluyó que tal violación se produjo debido a la existencia de discriminación basada en la condición de niña de la víctima y su etnicidad (Comité de Derechos Humanos, Dictamen del 18 de julio de 2011, Comunicación nº 1610/2007, CCPR/C/102/D/1610/2007).
Asimismo, el Comité consideró «que el trato recibido por esta [la menor víctima de la etnia Qom-Toba] en la comisaría de policía y en el puesto médico justo después de haber sufrido la agresión, así como durante el proceso judicial» y «las varias irregularidades acaecidas [en este]» significaron que el estado, ante su falta de refutación de las acusaciones, «[violó] el derecho de la autora a acceder a los tribunales en condiciones de igualdad».
Por último, el juez Maidana citó el informe temático («Tercer informe: La justicia y los derechos indígenas», 2004) elaborado por el Relator Especial de las Naciones Unidas sobre la situación de los derechos humanos y las libertades fundamentales de los pueblos indígenas, Rodolfo Stavenhagen, en relación con el acceso a la justicia por parte de quienes pertenecen a pueblos originarios.
El sentenciante expresó que este informe da cuenta de que, «en muchos países, los pueblos indígenas no disfrutan de igualdad de acceso al sistema de justicia y que, una vez ingresados a este, suelen ser objeto de diversas formas de discriminación, malos tratos y violencia, afirmando que las mujeres y niños indígenas son los más afectados».
Reprodujo textualmente la conclusión del Relator en cuanto a que, en gran parte de los Estados miembros y signatarios de diversos instrumentos internacionales para su protección, «la falta generalizada de acceso al sistema oficial de justicia debido a la discriminación directa o indirecta profundamente arraigada en contra de los pueblos indígenas, es un rasgo importante de las deficiencias en la protección de los derechos humanos».
El informe destaca, según el juez Maidana:
[L]a falta de acceso a la justicia y la discriminación dentro de su administración, se deben muchas veces al aislamiento físico y a la falta de medios de comunicación en las zonas indígenas, pero también a la ausencia de recursos públicos que sean suficientes para establecer un sistema judicial eficaz en el que se tengan en cuenta las necesidades de las comunidades indígenas.
Esto sería indicativo de que «la cultura jurídica oficial de un país no está adaptada para hacer frente al pluralismo cultural y que los valores dominantes de una sociedad tienden a ignorar, olvidar y rechazar las culturas indígenas».

Por último, el juez puso de relieve «que el informe subrayó la particular discriminación y prejuicios que sufren los indígenas en el sistema de justicia, especialmente en la justicia penal, y la situación de desventaja especial de mujeres, jóvenes y niños»
Además, el magistrado hizo expresa mención de la «Observación General 13 (OG.) del citado Comité de Derechos Humanos de la ONU (U.N. Doc. HRI/GEN/1/ Rev.7 at 154, 1984)» y dijo:
Esta OG., que interpreta el artículo 14 del PIDCP sobre administración de justicia, establece que, a pesar de la complejidad de su texto, la finalidad de todas sus disposiciones «es garantizar la adecuada administración de la justicia y, a tal efecto, afirmar una serie de derechos individuales, como la igualdad ante los tribunales y cortes de justicia y el derecho a ser oído públicamente y con las debidas garantías» (párr. 1).
Luego de manifestar que todas las circunstancias descriptas en los documentos internacionales que citó precedentemente se replican en la causa en estudio, el juez Maidana expresó sobre la condenada:
R. M. B. pertenece a una comunidad indígena, cuya vida se formó en una cultura distinta en la que, a modo de ejemplo, las controversias se esclarecen mediante la figura del Corregidor y no a través de un sistema de justicia igual o similar al argentino, circunstancia que posibilita afirmar su gran desconocimiento de la cultura imperante en este territorio y, en consecuencia, la coloca en una situación de desventaja y vulnerabilidad cuya obligación de remediar corresponde únicamente al estado argentino mediante las distintas instituciones públicas tales como la administración de justicia.
47 REVISTA CTPCBA | N.° 157 | ABRIL-JULIO |
Y destacó:
A todo ello aduno que la normativa y jurisprudencia internacionales califican como pauta discriminatoria grave la imposibilidad de una persona de expresarse en su lengua originaria, especialmente en circunstancias en las que esta se encuentra de alguna u otra forma involucrada en un proceso de justicia. [La negrita me pertenece].
Con cita de la OG 13, el juez señaló que esta norma «más específicamente establece que la primera de las garantías mínimas de un proceso penal, previstas en el párrafo 3 del artículo 14 del PIDCP, refiere al derecho de toda persona a ser informada, en un idioma que comprenda, de la acusación formulada contra ella» (la negrita me pertenece).
En la causa analizada por el Tribunal de Casación, surge: [L]a imputada tuvo serias dificultades para comunicarse en su lengua originaria —quechua— durante gran parte de la instrucción penal preparatoria en la que estuvo privada de su libertad, es decir, en el contexto de un proceso penal ajeno a la cultura en la que ella desarrolló la mayor parte de su vida, afectando inevitablemente los derechos antes citados de acceso igualitario a la justicia, no discriminación, igualdad ante la ley, a ser oída y de defensa, entre otros [La negrita me pertenece].
De ello se sigue que, tal como lo sostuvo el juez de Casación:
R. M. B. estuvo privada de su libertad y sin un intérprete designado formalmente desde el 20 de noviembre de 2010 hasta el 5 de septiembre de 2013 [...]. No puede soslayarse la situación, pues pone de manifiesto que no se trata de una circunstancia aislada en la causa, sino que se advierten la presencia de prejuicios socioculturales y falta de análisis del contexto culturalmente diverso de quienes se encuentran involucrados. [La negrita me pertenece].
Por eso colige que «[l]a ausencia de un análisis contextualizado afectó especialmente a la imputada en su condición de integrante mujer de una comunidad quechua, migrante, con poca instrucción, carente de recursos e impide establecer que en la sentencia haya habido un abordaje integral de las cuestiones correspondientes» (la negrita me pertenece).
El juez entendió que lo propio sucedió en la etapa del juicio oral:
[E]n donde se observa la falta de comprensión cabal del idioma castellano por parte de algunos testigos que claramente no entienden, por ejemplo, el significado de ciertas preguntas que efectúa la defensa a
la testigo F. S. acerca de la contextura física de R. [...] y a la testigo N. M. B., quien oportunamente solicitara declarar en quechua, acerca de la detención de R. y también de su estado físico de salud. [La negrita me pertenece].
El voto del juez Maidana prosiguió:
La República Argentina, además del cúmulo de tratados de derechos humanos con jerarquía constitucional y supralegal, es signataria y ha ratificado una serie de instrumentos internacionales referentes a los derechos de los pueblos originarios, instrumentos cuya finalidad principal es revertir la situación de vulnerabilidad y discriminación a la que dichas comunidades han sido sometidas por décadas, para lograr finalmente su igualdad en los distintos ámbitos públicos y privados de la sociedad.
Entre los instrumentos mencionó los Convenios 107 (de 1959) y 169 (de 1991) de la Organización Internacional del Trabajo (OIT) y la Declaración de las Naciones Unidas sobre los Derechos de los Pueblos Indígenas (2007), y concluyó que «la normativa internacional y nacional adoptada por el estado argentino busca la igualdad legal como elemento necesario para una igualdad real y fáctica que destruya los viejos paradigmas de superioridad cultural y, en consecuencia, de discriminación».
Luego de realizar un pormenorizado análisis de la perspectiva de género y la situación de la imputada con respecto a la violencia sufrida, el juez Maidana abordó el aspecto de la sentencia en crisis que está relacionado con la credibilidad que el Tribunal Oral le ha otorgado a la imputada, y que fue motivo de agravio presentado por su defensa.
Remitiendo a su análisis previo —que ya reproduje con fidelidad anteriormente—, para el magistrado:
[S]e evidencia una contextualización sociocultural y de género insuficientes en referencia a la acusada, que inevitablemente conduce a la formación de ciertos prejuicios sobre ella y cuyo resultado es una ausencia de credibilidad sobre su manejo del idioma castellano y acerca de la violencia de género de la que fuera víctima y, en consecuencia, sobre su versión de lo ocurrido la noche del hecho en cuestión. Es decir, tal presunción de mendacidad acerca de sus circunstancias personales influye en la construcción de su culpabilidad como coautora de la muerte de quien fuera su pareja. [La negrita me pertenece].
Finalmente, refirió que «entendió el Tribunal que la imputada comprende y puede expresarse perfectamente en el idioma castellano porque E. S. A., tía de la víctima, dijo que “manejaba los dos idiomas...”».
| REVISTA CTPCBA | N.° 157 | ABRIL-JULIO 48
Derechos
EL MUNDO
y traducción
DE LA TRADUCCIÓN
El traductor público, el idioma nacional y la lengua materna: vulnerabilidad y derechos
Sin embargo, del cotejo de las afirmaciones del Tribunal Oral con las constancias del legajo criminal, para el juez Maidana:
[S]urgen serias evidencias que se oponen a lo sostenido y me llevan a concluir lo contrario, es decir, que la imputada no posee el conocimiento suficiente del idioma castellano como para desenvolverse sobradamente en un proceso penal con un lenguaje científico específico —muchas veces incluso desconocido e inentendible para personas cuya lengua originaria es el castellano— y, de este modo, transmitir sus pensamientos, comprender el contexto y ejercer correctamente su Defensa [La negrita me pertenece].
Agregó lo siguiente:
Además de que la propia imputada manifestara su falta de comprensión del idioma castellano, la Licenciada Liliana Beatriz Camarón, en el debate oral declaró que, durante las entrevistas que mantuvo con la imputada, recurrió muchas veces a la intérprete Frida Rojas por la dificultad que R. M. B. presentaba en el entendimiento del lenguaje castellano y del sentido de las preguntas que la profesional le efectuaba. [La negrita me pertenece].
Lo mismo refirió respecto del informe efectuado por la doctora Karina Bidaseca, en el que «se menciona de manera tajante que la imputada “no hablaba ni comprendía el castellano”, dependiendo de su pareja, L. S. V., para desenvolverse en cada uno de los aspectos de la nueva vida a la que fue incorporada» (la negrita me pertenece).
En idéntico sentido:

[S]urge del Amicus Curiae presentado por la Comisión Provincial por la Memoria y otras organizaciones especialistas en la materia, que R. M. B. «no hablaba ni comprendía cabalmente el idioma castellano debido a que es una indígena quechuaparlante, y que se encontraba en el país desde hacía poco más un año y medio» en el momento en que miembros de dicho organismo provincial la conocieron ya privada de su libertad en la UP. 33 [...]. En dicho documento se explicó que a raíz de tal circunstancia, la Comisión comenzó con las gestiones necesarias para obtener la designación formal de una intérprete. [La negrita me pertenece].
El magistrado entendió lo siguiente:
[N]ingún informe científico es necesario para concluir razonadamente que resulta difícil, sino imposible, que una persona migrante de una zona rural aislada, originaria de un pueblo indígena quechuaparlante en el que desarrolló la mayor parte de su vida y con ninguna instrucción formal en lengua castellana, pueda dominar lo suficientemente bien aquel idioma como para desenvolverse sin inconveniente alguno en el sistema de justicia argentino. Es por ello que numerosos tratados y jurisprudencia internacionales de derechos humanos enfatizan en la necesidad de tener una perspectiva multicultural en donde el mayor problema resulta ser la barrera idiomática.
La falta de comprensión cabal del idioma castellano (o de cualquier idioma venido el caso) hace que, inevitablemente, la información que se transmite y que se recibe no tenga siempre el significado que los interlocutores le quisieron dar, poniendo en serios riesgos la veracidad de lo transmitido.
Por estas razones, el juez Maidana entendió que «el juzgamiento de R. M. B. está sujeto a patrones culturales y sociales diversos a los suyos», y concluyó:
[E]sto implica una ausencia de perspectiva multicultural, intercultural y de género pues, como ya lo mencionara la Corte IDH y lo establecieran diversos documentos específicos de la materia, no se puede ni se debe juzgar a una persona aplicando estándares absolutamente distintos a los que esta posee, sino que deben obligatoriamente adoptarse las perspectivas mencionadas (Arts. 8 y 9 del Convenio 169 OIT). [La negrita me pertenece].
El magistrado sostuvo: «En conclusión, la falta de precisiones surgen como evidentes, imposibilitando concluir con certeza que R. M. B. mintió cuando dijo que hubo un altercado entre las personas mencionadas y que luego derivara en la muerte de L ».
En cuanto al agravio de la defensa referido a la impugnación de la interpretación del Tribunal Oral con respecto a la declaración del menor hijo de la imputada —Kevin— en la Cámara Gesell, el juez Maidana se manifestó en primer término sobre la cuestión idiomática.
El Tribunal Oral resaltó que Kevin se expresó en un castellano perfectamente entendible. Para el magistrado de la Cámara de Casación, tal afirmación resulta insostenible. Sostuvo: «[P]uede evidenciarse, sin dubitación
49 REVISTA CTPCBA | N.° 157 | ABRIL-JULIO |
EL MUNDO DE LA TRADUCCIÓN
Derechos y traducción
El traductor público, el idioma nacional y la lengua materna: vulnerabilidad y derechos
alguna, que el menor utiliza terminología proveniente de su lengua originaria quechua y alterna entre esta y el castellano, a la vez que utiliza expresiones o vocablos incomprensibles que me permiten afirmar que no puede expresarse con absoluta claridad» (la negrita me pertenece).
El juez Kohan votó en idéntico sentido y, en consecuencia, el Tribunal de Casación resolvió absolver a la imputada, por el beneficio de la duda, ya que no encontró certezas acerca de su participación en el homicidio enrostrado y, por ende, operó el principio de inocencia, y se ordenó su inmediata libertad.
Este caso nos lleva a reflexionar sobre la cuestión de las lenguas originarias —o lenguas indígenas, como también se denominan—, pero además en el marco del rol del traductor público en función de lo prescripto en los artículos 3 y 5 de la Ley 20305, de la que el 25 de abril se cumplen cincuenta años desde su sanción.
La cuestión de las lenguas indígenas ha sido abordada por diversos autores en nuestro país, como Ricardo Rojas en su célebre Eurindia y Jorge Ábalos en su no menos célebre Shunko.
Respecto de este último, vale rememorar su introducción dirigida al lector:
Los niños de quienes aquí te hablaré son changos santiagueños [...]. Responden a otra mentalidad y a otra cultura. Sus vidas están regidas por la superstición y la leyenda. Creeme que hasta tienen una religión que no es la tuya. Es una corriente que circula a la par de la nuestra y que nosotros no vemos. Ellos son otra cosa que nosotros. [...]. No te extrañes que el castellano que pongo en boca de esos changos no sea el castellano-criollo de los cuentos campesinos. He de recordarte que ellos habitan una región comprendida en esa curiosa ínsula situada dentro de nuestra provincia donde se habla el quichua peruano del siglo xvii, lengua general de los indios introducida por los misioneros y colonizadores españoles. Como quizás estos niños hablan bien su idioma indígena, me he creído en la obligación de verterlo a un castellano más o menos correcto.
Otra mentalidad, otra cultura, otra religión. Que circula entre nosotros, pero que no es la nuestra. Otro idioma. Un idioma indígena que no es el castellano, sino el quichua peruano del siglo xvii. Y cuatro siglos después lo siguen hablando. Como decía Ludwig Wittgenstein, en su Tractatus: «Los límites de mi lenguaje significan los límites de mi mundo». Y, sin embargo, en el siglo xxi se los juzga con parámetros de otro mundo y sin un traductor público-intérprete que garantice sus derechos.
Eso me recuerda a Pirandello, cuando uno de sus Seis personajes en busca de autor —«El Padre»—, quien pretende dar su versión de los hechos con sus propias palabras para defenderse de la acusación que en su contra hizo «La Hijastra», dice:
Cada uno en su interior posee su propio mundo de objetos. ¿Pero cómo nos vamos a entender si mis palabras encierran el sentido y el valor de las cosas tal como las siento en mi interior y quien las escucha les otorga el sentido y el valor que tienen para él? Creemos entendernos pero nunca lo hacemos.
Y se está refiriendo al entendimiento dentro de la misma mentalidad, de la misma cultura, en definitiva, del mismo mundo, de la misma lengua materna, donde el traductor público-intérprete no es imprescindible.
Y eso me reporta a Barbara Cassin —la autora de Elogio de la traducción— cuando nos señala en Más de una lengua que la lengua materna:
Es la lengua que hablamos, en la que nos bañamos al nacer; la lengua que nos rodea en casa, en familia [...]. Algunos de ustedes tienen quizá, dos lenguas maternas, [...] porque la lengua de su madre y la de su padre no son la misma. O bien porque la lengua que habla su familia y en la que están inmersos está ligada de manera inmediata a [...] la lengua del país en el que están, aquella en la que les hablan.
La lengua materna es entonces, para esta filósofa francesa, aquella (o aquellas) en la que nacimos y no es la única posible. «Es la que nos acompañará [...] toda la vida, la lengua en la que soñamos. ¿Alguna vez se preguntaron en qué lengua sueñan?», nos interroga. Y nos remite a Derrida en El monolingüismo del otro.
Al referirse a la traducción, Cassin sostiene: «Para pasar de una lengua a la otra, tenemos que pasar de un mundo a otro, hay que atravesar un foso». Y afirma que «una lengua no es simplemente un medio para comunicarse: es también una cultura, un mundo de frases, de ritmos que difieren».
El quechua o quichua, conocido como quechua sureño, en quechua urin qhichwa o simplemente qhichwa, es una lengua indígena oficial a nivel nacional en Bolivia, país de origen y proveniencia de la imputada —y condenada después absuelta— Reyna Maraz Bejarano. El quechua o quichua también se habla —pero sin ser idioma oficial en la Argentina— en la provincia de Santiago del Estero, la cuna de Shunko.
En nuestra ley de ejercicio profesional y creación del CTPCBA se estableció —hace ya cincuenta años— que la función del traductor público, que además se encuentra autorizado a desempeñarse como intérprete, es la
| REVISTA CTPCBA | N.° 157 | ABRIL-JULIO 50
de traducir del «idioma extranjero al idioma nacional y viceversa».

¿Es el quichua un idioma extranjero o es considerado parte del idioma nacional? ¿Cuál es realmente el «idioma nacional» al que refiere el artículo 5 de la Ley 20305?
¿El castellano? ¿El español? ¿Existe? ¿En qué norma está regulado o definido?
En ese sentido, no puedo más que respetuosamente disentir de la tesis elaborada en la obra Más de 555 millones podemos leer este libro sin traducción. La fuerza del español y cómo defenderla —en particular, la perteneciente a Ricardo Ávila, titulada «El español sin traductores para más de 500 millones»—, que no contempla que no sea el castellano, reconociendo tácitamente la inexistencia del idioma español, «[e]se idioma que nos acompaña desde la cuna hasta el cementerio, ese idioma con el cual pensamos, soñamos, amamos, discutimos y nos ponemos de acuerdo: ese idioma que nos permite comunicarnos en Europa y en América entre 500 millones de hispanohablantes». Milciades Ramón Vázquez Quiroga y Reyna Maraz Bejarano, con su guaraní del Paraguay y su quichua de Bolivia natales precolombinos, respectivamente, dan fe, junto con nuestro Shunko, de que tal afirmación no es cierta en la libertad de la pluralidad lingüística y cultural. También lo desmienten Cassin y Derrida. Por cierto, no «hablamos la misma lengua», como pretende Santiago Muñoz Machado, porque no es cierto que el castellano sea la lengua principal de América. Por el contrario, comparto lo expresado por Lola Pons Rodríguez en El árbol de la lengua:
Cuando nos olvidemos de la idea de que a un país le ha de corresponder una sola lengua; [...] cuando las lenguas no sean ni la jaula ni el ariete. Entonces nuestra cultura lingüística corresponderá a las inmensas capacidades de nuestra lengua. Entonces, y solo entonces, estaremos como hablantes a la altura de ese árbol gigante que nosotros mismos hemos creado.
Y los traductores públicos, junto con los demás traductores e intérpretes que no lo son, en franca colaboración con lingüistas, filólogos y juristas, trabajaremos codo a codo para garantizar el ejercicio efectivo de los derechos de entender y ser entendido como un inmanente derecho humano.
Por esa razón, son todos interrogantes planteados en párrafos anteriores los que deben responderse en casos judiciales como el aquí reproducido y comentado, donde,
como vimos, se violan derechos fundamentales por no designarse a los únicos profesionales capaces de garantizar la tutela judicial efectiva del derecho de entender y ser entendido que el Estado argentino debe cumplir y hacer cumplir como país signatario de tratados de derechos humanos con jerarquía constitucional.
Es imprescindible, por el rol que desempeña en los procesos penales, el traductor público-intérprete, toda vez que es el único profesional con los conocimientos técnicos, tanto idiomáticos como jurídicos en razón de su rigurosa formación académica, en condiciones de garantizar la efectiva tutela de los derechos lingüísticos de aquellos que por su estado de vulnerabilidad —sean imputados, víctimas o simplemente testigos— tengan la imperiosa necesidad de entender o de ser entendidos, de comprender y de ser comprendidos, en un ámbito donde además de una lengua extraña deban enfrentarse con un lenguaje o jerga especializada como lo es el jurídico.
Esa es la misión fundamental del traductor público-intérprete. Porque, recordemos siempre y hagámoslo valer en todos los ámbitos de nuestras incumbencias profesionales y en particular en el ámbito judicial, sin traductor público no hay derechos, sin derechos no hay justicia y sin justicia no hay Estado democrático de derecho.
51 REVISTA CTPCBA | N.° 157 | ABRIL-JULIO |
Noticias de la traducción
debe saber escuchar lo que el autor le sopla al oído»
La traductora mexicana Selma Ancira habló ante la comunidad universitaria de la Unidad de Humanidades de la Universidad Veracruzana (UV) de México y expresó: «Uno de los aprendizajes más importantes para el traductor literario es escuchar lo que le sopla el autor al oído».
A invitación de la Dirección Editorial y de las Facultades de Letras Españolas e Idiomas de la Universidad Veracruzana, Selma Ancira participó en la charla «El jardín exótico del traductor literario», junto con José Luis Rivas, escritor y poeta veracruzano.

A propósito del tema de la charla, Selma Ancira hizo una comparación metafórica al exponer que el traductor tiene alma de jardinero por su deambular por los jardines, vergeles y huertos de las literaturas extranjeras en las que se mueve con soltura. De pronto, encuentra y descubre nuevos brotes, flores y árboles ya crecidos y ajenos a su cultura.
«Si con algunos de esos retoños el alma del traductor vibra, lo que se apodera de él son las ganas de traducirlos, de traerlo y que llegue a formar parte de la cultura en la que nació y habita».
Manifestó que los traductores gustan de compartir la belleza y los hallazgos, son personas con una necesidad profunda de dar a conocer lo que por azares de la vida les tocó vivir.
Sin saber que algún día llegaría a ser traductora, precisamente, por azares de la vida es hablante del idioma ruso y griego, y ahora disfruta traer a los autores de esas culturas al español.
«Yo trasplanto y desarraigo esa planta exótica, la traigo y la siembro en este idioma que es el nuestro, pero no me tengo que conformar con trasplantarla, después tengo que cultivarla porque de lo contrario se muere».
Por tanto, consideró que una parte muy importante del trabajo del traductor es cultivar lo que ha trasladado, propiciar que de esa pequeña planta devenga un árbol grande, frondoso, y pueda expandirse en el espacio lingüístico del traductor.
«Son varias las plantas exóticas que florecen en el jardín, producto de décadas, de paseos por mis huertos preferidos, el huerto de la literatura rusa y griega».
Sin embargo, compartió con los estudiantes universitarios, que se mantuvieron atentos a la charla, que hay dos plantas exóticas que no existían en el idioma español, y que por azar las descubrió: Marina Tsvietáieva y María Iordanidu, escritora rusa y novelista griega, respectivamente.
Marina Tsvietáieva es su pasión, a ella le debe su vocación, le despertó sus ganas de traducir, compartir y darla a conocer. «Sin ella no sería lo que soy, quizá sería antropóloga o camarógrafa, otra de mis pasiones junto con el cine».
Recuerda que un día, durante su época de estudiante en la Universidad Estatal de Moscú, a petición de su padre, quien es actor, acudió a la agencia de derechos de autor donde le entregarían una obra de teatro en idioma ruso. Era amiga de uno de los colaboradores del lugar, y este le dio un paquete cerrado con la encomienda de no abrirlo hasta su llegada a la residencia estudiantil donde vivía y de regresarlo al lunes siguiente.
Cuando llegó, de inmediato abrió el paquete y se encontró con unas cartas que Marina Tsvietáieva escribió con dedicatoria a Rainer Maria Rilke, poeta y novelista austríaco.
Sorprendida por el hallazgo y motivada por la profundidad de las palabras, gracias a eso sintió la necesidad de traducirlas y trasladarlas a su lengua. Al hacerlo, la traducción literaria se volvió una práctica cotidiana y su razón de ser.
Pero su aprendizaje apenas comenzaba, dijo, había sentido el milagro de ver las imágenes que la conmovieron en una lengua extranjera y tejerlas en español con los elementos y herramientas que le dio su propio idioma.
Poco a poco, entendió que cada autor pide ser traducido de una forma distinta. Otro de los aprendizajes es saber leer lo que cada libro pide que leas.
| REVISTA CTPCBA | N.° 157 | ABRIL-JULIO 52
Las noticias más curiosas sobre la traducción EL MUNDO DE LA TRADUCCIÓN
«El traductor
Fuente: Universo. Sistema de noticias de la UV
Por Claudia Peralta Vázquez «Uno de los aprendizajes más importantes para el traductor literario es escuchar lo que le sopla el autor al oído» (Selma Ancira)
La traducción de la Biblia, ¿una tarea posible?

La Biblia se ha escrito para ser traducida. Aquel que dijo «Id y haced discípulos a todas las naciones… Y yo estoy con vosotros hasta la culminación del tiempo» (Mateo 28, 19-20) estaba encomendando a los Doce la tarea de llevar el Evangelio a todos los hombres de todos los tiempos. Y eso ha requerido, requiere y requerirá la traducción. Por eso, cada generación está llamada a traducir la Biblia.
Traducción y «traición»
La teoría lingüística explica que la traducción exacta es imposible, ya que cada lengua es distinta e impide las equivalencias automáticas entre términos y expresiones; por ello, el acto de traducción es ya una interpretación. Pero esto, inevitable, permite también la transmisión del mensaje. Se ha hecho famoso el lema italiano traduttore traditore, «traductor traidor»; es imposible una traducción ciento por ciento exacta. Pero la expresión también se podría traducir como «traductor transmisor» (traditore deriva de traditio, ‘tradición’): el traductor se convierte así en canal para perpetuar un texto.
La traducción es un arte delicado, pues requiere una doble fidelidad: al autor y al lector; pero esta tensión no es excluyente, sino fecunda. Además, la traducción de la Biblia es, si cabe, más compleja, porque al autor humano se une el Autor divino. Por ello, entre la fidelidad al lector y la fidelidad al Autor, ha de prevalecer la segunda, como sostenía el padre Manuel Iglesias, eminente traductor del Nuevo Testamento al castellano en los últimos
cincuenta años. Sin embargo, este nuevo «actor» genera un hecho singular: porque resulta que ese Autor, Dios, está vivo, y por lo tanto es capaz de hablar hoy a través de una palabra de ayer.
Por eso, todo intento de despojar la palabra de su misterio ha de ser desechado. Corresponde al lector creyente entrar en ese misterio para descubrir la luz que despliega. Por ello, la traducción ha de buscar siempre la fidelidad al original, siempre dentro —claro está— de la máxima corrección y cuidado lingüísticos. Corresponderá al editor el proporcionar (en introducciones o notas) aquellas explicaciones que considere necesarias para iluminar esa traducción, indicar otras traducciones posibles y mostrar su actualidad.
La Sagrada Escritura
y la liturgia
Teniendo en cuenta todo lo anterior, hay diversos tipos de traducciones; no es lo mismo, por ejemplo, una traducción de estudio (que privilegia una cercanía
máxima a las lenguas originales: hebreo, arameo o griego) que una traducción litúrgica (en la que prima la sobria y digna belleza en orden a la proclamación). Pero todas ellas han de expresar esa doble fidelidad que, privilegiando al Autor, busca iluminar la mente y el corazón del lector.
Por último, nótese que la lectura de la Sagrada Escritura es siempre un acto eclesial; por ello, su ámbito más propio es la liturgia. En ese contexto, no hay miedo de perder datos esenciales: el Espíritu Santo se ocupa de introducir al oyente o lector, por medio de esta palabra, en la Revelación del Dios vivo. La Biblia, entregada al pueblo de Dios, permite a todo cristiano entrar en esa relación de amor; por ello, la Iglesia nos enseña que los santos nos dan la «traducción» genuina del Evangelio (véase Benedicto XVI, exhortación apostólica Verbum Domini, n.º 48-49).
Fuente: Omnes
53 REVISTA CTPCBA | N.° 157 | ABRIL-JULIO |
Por Luis Sánchez Navarro
La Sagrada Biblia (Unsplash/Priscilla Du Preez)
NORMATIVA DEL ESPAÑOL, GRAMÁTICA
¡¿Por las dudas...?!
Zorrilla, Alicia María

Buenos Aires: Libros del Zorzal, 2022, 256 pp.
«Titulamos nuestro libro ¡¿Por las dudas...?!, con signos de exclamación y de interrogación al mismo tiempo, para expresar enfáticamente que lo escribimos “por las dudas” que nos acosan día a día cuando usamos nuestra lengua (la transgresión del significado de las palabras, la puntuación, los gerundios, los desdoblamientos léxicos, los tiempos verbales, los desaciertos gramaticales, los géneros femenino y masculino, etcétera) y “por las dudas” de que algunos hablantes no se sientan aún afligidos por aquellas, ya que, vacíos de cultura idiomática, viven anclados en el oscuro desinterés que genera sus graves errores lingüísticos. Los puntos suspensivos dejan abiertas las dos posibilidades» (Alicia María Zorrilla).

ESPAÑOL, ETIMOLOGÍA
El apasionante origen de las palabras
Balmaceda, Daniel

Buenos Aires: Sudamericana, 2021, 428 pp.
Un fascinante recorrido por la historia de las palabras, desde las que empezaron a formar parte de nuestro vocabulario en los últimos tiempos (como deadline, free-lance, target) hasta frases que usamos sin saber muy bien qué significan (Quedar en Pampa y la vía). En el camino, el autor nos descubre secretos de la historia universal y de sus curiosos personajes.
La palabra es una herramienta poderosa y admirable. Indagar en su historia es sumergirnos en nuestra propia historia.
INVESTIGACIÓN EN TRADUCCIÓN, TRADUCCIÓN CIENTÍFICO-TÉCNICA
ENSAYOS, FILOSOFÍA DEL LENGUAJE
Más de una lengua
Cassin, Barbara; Waksman, Vera (traductora)
Buenos Aires: Fondo de Cultura Económica, 2014, 62 pp.
Todos nacemos en la lengua o las lenguas que se hablan alrededor nuestro. Pero ¿qué es una lengua «materna»? ¿Y qué ocurre cuando se aprende otra? Si cada lengua dibuja un mundo diferente, ¿qué es lo que se dibuja cuando se habla más de una? Hablar varias lenguas equivale a tener varios mundos al alcance. Pasar de una lengua a la otra, aprendiendo, traduciendo, es aventurarse en otra manera de transmitir el sentido. Todas esas maneras, cuando entran en contacto, se enriquecen: comprendemos mejor lo que intentamos decir cuando sabemos que eso se dice de otro modo en otra lengua, con otras palabras, que quizá no dicen exactamente lo mismo.
Más de una lengua surge de una conferencia de Barbara Cassin dirigida a niños a partir de 10 años y a sus acompañantes. Allí se interroga, desde la filosofía, acerca de temas tan complejos como el significado del logos para los griegos, la traducción, las riquezas del bilingüismo, los homónimos y los intraducibles.
Scientific and Technical Translation

Explained: A Nuts and Bolts Guide for Beginners
Byrne, Jody
Abingdon: Routledge, 2014, 229 pp.
From microbiology to nuclear physics and chemistry to software engineering, scientific and technical translation is a complex activity that involves communicating specialized information on a variety of subjects across multiple languages. It requires expert linguistic knowledge and writing skills, combined with the ability to research and understand complex concepts and present them to a range of different audiences. Using a combination of interdisciplinary research, real-world examples drawn from professional practice and numerous learning activities, this introductory textbook equips the student with the knowledge and skills needed to get started in this exciting and challenging field. It examines the origins and history of scientific and technical translation, and the people, tools and processes involved in translating scientific and technical texts. Scientific and Technical Translation Explained provides an overview of the main features of scientific and technical discourse as well as the different types of documents produced. A series of detailed case studies highlight various translation challenges and introduce a range of strategies for dealing with them. A variety of resources and exercises are included to make learning effective and enjoyable.
| REVISTA CTPCBA | N.° 157 | ABRIL-JULIO 54
Nuestra Biblioteca BIBLIOTECA
Biblioteca Bartolomé Mitre
Librería del Traductor Jorge Luis Borges
MANUAL, ESTUDIOS DE TRADUCCIÓN, AUDIODESCRIPCIÓN

The Routledge Handbook of Audio Description
Taylor, Christopher; Perego, Elisa
Nueva York: Routledge, 2022, 666 pp.
This Handbook provides a comprehensive overview of the expanding field of audio description, the practice of rendering the visual elements of a multimodal product such as a film, painting, or live performance in the spoken mode, for the benefit principally of the blind and visually impaired community. This volume brings together scholars, researchers, practitioners and service providers, such as broadcasters from all over the world, to cover as thoroughly as possible all the theoretical and practical aspects of this discipline.
In 38 chapters, the expert authors chart how the discipline has become established both as an important professional service and as a valid academic subject, how it has evolved and how it has come to play such an important role in media accessibility. From the early history of the subject through to the challenges represented by ever-changing technology, the Handbook covers the approaches and methodologies adopted to analyse the «multimodal» text in the constant search for the optimum selection of the elements to describe.

This is the essential guide and companion for advanced students, researchers and audio description professionals within the more general spheres of translation studies and media accessibility.
LENGUAJE Y SOCIEDAD, LENGUAJE INCLUSIVO
La lengua en disputa. Un debate sobre el lenguaje inclusivo
Sarlo, Beatriz; Kalinowski, Santiago
Buenos Aires: Godot, 2019, 81 pp.
Este libro es el resultado de un debate que tuvo lugar en el marco de la octava Feria de Editores bajo el título «La lengua en disputa». El texto es la desgrabación corregida del intercambio que se dio entre Beatriz Sarlo (ensayista, crítica y docente universitaria) y Santiago Kalinowski (director del Departamento de Investigaciones Lingüísticas y Filológicas de la Academia Argentina de Letras). La intención fue replicar una lógica de debate tradicional, en la que los invitados conocieran de antemano los ejes sobre los cuales se iba a discutir para poder preparar sus argumentos. En pocas páginas se estructuran las principales objeciones o beneficios del uso del lenguaje inclusivo. El registro oral del libro permite que los argumentos se intercalen con sencillez, sin perder su profundidad. Un texto ideal para disparar discusiones por venir.

FONDO EDITORIAL, DERECHO Diccionario de procedimiento parlamentario español-inglés, inglés-español
Magee, María Cristina
ARGENTINA, DERECHO CIVIL, FRANCÉS
Code civil et commercial argentin

Rodriguez, Beatriz (traductora); Drienisienia, Alide (traductora)
Buenos Aires: IJ Editores, 2020, 695 pp.
«Jorge Luis Borges, écrivait dans Le livre de Sable, “Les mots sont des symboles qui postulent une mémoire partagée”. La phrase est connue mais elle trouve un écho particulier ici, car les mots de la langue du Droit que nous avons en commun sont la marque et l’expression d’un passé partagé et, j’ose le prophétiser, d’un avenir de collaboration sans cesse croissante. Les premières codifications en Argentine remontent au XIXème siècle avec, comme en France, un Code civil et un Code de commerce distincts. Le nouveau Code promulgué en 2014 entend régir á la fois le Droit civil et le Droit commercial» (Didier Guével).
Buenos Aires: CTPCBA, 2010, 319 pp.
Este diccionario pretende abarcar la mayor cantidad de términos específicos sobre procedimientos parlamentarios. Desde siempre en nuestro país, la traducción de las diversas instancias del procedimiento parlamentario ha causado dificultades que, en ocasiones, han llevado a graves errores de interpretación que ni el paso del tiempo ha logrado subsanar. Como sucede con la jerga de toda especialidad, el vocabulario utilizado en el Congreso y en las legislaturas provinciales y municipales para el tratamiento de sus iniciativas legislativas es específico, y todo intento de alejarse de él puede llevar a desinteligencias y situaciones engorrosas. Entender temas relativos a los procedimientos de dos países de hablas y tradiciones diferentes suele ser complejo, y más aún cuando se trata de hacer coincidir su terminología, que, por lo estricta, requiere precisión en la elección de los términos para que estos no pierdan la esencia de su significado en la aplicación de dichos procedimientos.
55 REVISTA CTPCBA | N.° 157 | ABRIL-JULIO |
Novedades del servicio de ventas LIBRERÍA
Agenda nacional e internacional
Aporte de la Comisión de Relaciones Internacionales.
20-23
VII Congreso Latinoamericano de Traducción e Interpretación
Colegio de Traductores Públicos de la Ciudad de Buenos Aires
País: Argentina Ciudad: Buenos Aires
URL: https://www.traductores.org.ar/congresos-y-foros/viicongreso-latinoamericano-de-traduccion-e-interpretacion/



26-29
V Congreso Internacional sobre la Lengua de la Vid y el Vino y su Traducción
Facultad de Traducción e Interpretación de Soria
País: España Ciudad: Soria
URL: https://girtraduvino.com/es/congresos/ver/181/v-congresointernacional-sobre-la-lengua-de-la-vid-y-el-vino-y-su-traduccin/
27-28
International Conference on Languages, Literature and Translation Studies


FTI-EII
País: Bélgica Ciudad: Mons
URL: https://web.umons.ac.be/fti-eii/fr/evenements/ langues-lettres-et-traductologie-quels-enseignements-dupasse-pour-relever-les-defis-de-lavenir%e2%80%89/
27-28 4-5
II Congreso Internacional de Lingüística Digital

Universidad de Alicante
País: España Ciudad: Alicante
URL: https://web.ua.es/es/cilidi/pagina-de-inicio-del-sitio.html
3rd Annual Conference of the Translation Studies Network of Ireland: Radical Translation(s)/Translating the Radical University College Cork

País: Irlanda Ciudad: Cork
URL: http://casilac.ie/portfolio-item/cfp-radical-translationstranslating-the-radical/

8-10
BP Translation Conference
BP Translation Conferences
Híbrido: Utrecht (Países Bajos)/en línea
URL: https://bpconf.com/BP23/
| REVISTA CTPCBA | N.° 157 | ABRIL-JULIO 56
Eventos relacionados con la traducción y la interpretación AGENDA ABRIL MAYO
Congreso 20.º Aniversario de Asetrad
Asetrad

País: España Ciudad: Las Palmas de Gran Canaria
URL: https://xxcongreso.asetrad.org/
17-19
VI Congreso Internacional Ciencia y Traducción
Universidad de Córdoba (España), Università Ca’Foscari
Venezia, Campus Treviso (Italia)
Híbrido: Córdoba (España) y Treviso (Italia)/en línea
URL: https://congresointernacionalcienciaytraduccion.es/

19-21
8th Young Linguists’ Meeting in Poznań: «Language and communication in the times of crisis»

Faculty of English, Adam Mickiewicz University
País: Polonia Ciudad: Poznan
URL: https://ylmp2023.amu.edu.pl/
25-27
6th International Conference on Non-Professional Interpreting and Translation
Department of English Studies, University of Cyprus
País: Chipre Ciudad: Nicosia
URL: https://www.npit6.com/

31 DE MAYO AL 2 DE JUNIO
II Congreso Internacional sobre Traducción e Interpretación: «Traducción como mediación (inter)cultural»

Universidad Rey Juan Carlos
País: España Ciudad: Aranjuez
URL: https://eventos.urjc.es/94484/detail/ii-congresointernacional-de-traduccion-e-interpretacion-traduccioncomo-mediacion-intercultural.html
Semmelweis Medical Linguistics Conference 2023: Impact of Sociocultural Factors on Health Communication Hybrid Conference
Department of Languages for Specific Purposes, Semmelweis University

País: Hungría Ciudad: Budapest
URL: https://semmelweis.hu/szaknyelv/en/smlc2023/
L’auteur face à son traducteur: la généalogie d’une relation asymétrique
Université de Tours

País: Francia Ciudad: Francia
URL: https://www.fabula.org/actualites/109217/lauteurface-a-son-traducteur--la-genealogie-dune-relation.html
24th Annual Conference of the European Association for Machine Translation
European Association for Machine Translation y Tampere University

País: Finlandia Ciudad: Tampere
URL: https://events.tuni.fi/eamt23/
3rd Conference of the Association for Translation Studies in Africa: Cameroon 2023

Advanced School of Translators and Interpreters, University of Buea Híbrido: Buea (Camerún)/en línea
URL: https://atranslationstudiesafrica.wordpress.com/atsaconference-2023/
International Symposium on Bilingualism

Macquarie University
País: Australia Ciudad: Sídney
URL: https://www.isb14.com/home
57 REVISTA CTPCBA | N.° 157 | ABRIL-JULIO |
MAYO JUNIO
11-12 2-3 12-13 12-15 20-24 26-30
Juras
FELICITAMOS A LOS NUEVOS MATRICULADOS.








| REVISTA CTPCBA | N.° 157 | ABRIL-JULIO 58
Nuevos matriculados del CTPCBA JURAS 9490 GOLDMANN, SUSANA LUISA XXIII 402 9491 PIERDOMINICI, YAMILA BELÉN XXIII 403 9492 CASTRO, BRENDA INÉS XXIII 404 9493 HERRERA, MARCELA ISABEL XXIII 405 9494 GONZÁLEZ, SEBASTIÁN XXIII 406 9495 VÁZQUEZ, CAMILA GIMENA XXIII 407 9496 MÉRIDA, CAROLINA JUDITH XXIII 408 9497 GARCÍA, RUTH VERÓNICA XXIII 409 9498 BARROS, CARLOS ALBERTO XXIII 410 9499 ROMANO, MICAELA SOL XXIII 411 9500 FERNÁNDEZ CUPEIRO, GUADALUPE BELÉN XXIII 412 9501 GERVASI, PAULA DANIELA XXIII 413 9502 ERCOLANO, FRANCO XXIII 414 9503 WAISVOL, ESTEFANÍA XXIII 415 9504 GARAVAGLIA, GRACIELA MARIANA XXIII 416 9506 PARODI, CANDELA JULIANA XXIII 417 9507 SEJAS RODRÍGUEZ, AGUSTINA SOFÍA XXIII 418 9508 LARROZA DELESTAL, PAULA SOFÍA XXIII 419 9509 SEPÚLVEDA, MARÍA ALEJANDRA XXIII 420 INGLÉS ALEMÁN
Capacitación en el CTPCBA
Toda la información detallada sobre los cursos del CTPCBA se encuentra disponible en el sitio web www.traductores.org.ar, en la sección «Capacitación».

www.traductores.org.ar/capacitacion/actividades/ www.traductores.org.ar/capacitacion



















BENEFICIOS TECNOLÓGICOS PARA LOS MATRICULADOS
Stilus, mucho más que el mejor corrector ortográfico y gramatical en español, ofrece un 15 % de descuento. Para obtener más información, visite http://www.mystilus.com

30 %
AIT Translation Management Solutions ofrece un 30 % de descuento para la compra de los software AnyCount, Translation Office 3000, Projetex 3D, AceProof y ExactSpent, que serán más que útiles para los profesionales de la traducción. Para obtener más información, visite https://www.translation3000.com


15 %
EZTitles, empresa líder en el desarrollo de herramientas para la traducción audiovisual, ofrece un 15 % de descuento en sus productos.

Para obtener más información o ver una demostración, visite http://www.eztitles.com/index.php
OFERTAS ESPECIALES
IntelliWebSearch está diseñado para que los traductores e intérpretes ahorren tiempo al buscar vocabulario en la web. Simplemente hay que presionar una tecla de acceso directo y el texto seleccionado en su entorno de traducción se copia. Luego, se abre su navegador y envía el texto copiado a los motores de búsqueda, diccionarios o enciclopedias en línea, o sitios web que haya seleccionado. De esta manera, la búsqueda se realiza en todos los lugares seleccionados al mismo tiempo.
Para obtener mas información, visite https://www.intelliwebsearch.com

Wordfast ofrece un 30 % de descuento en Wordfast Pro, Wordfast Classic o Wordfast Studio sobre el precio especial para América Latina (que ya tiene un 50 % de descuento sobre el precio oficial).
Para obtener más información, visite https://wordfast.com
Gespoint ofrece un 10 % de descuento en su software de gestión empresarial diseñado especialmente para empresas y profesionales de la traducción.
Para obtener más información, visite http://www.gespoint.com

15 % 30 % 10 % 30 %
TransPDF termina con la frustración de traducir archivos PDF al convertirlos a XLIFF de buena calidad para que puedan usarse herramientas de traducción. Simplemente, cargue su archivo a TransPDF y traduzca el XLIFF que obtiene utilizando sus propias herramientas; el sistema admite una amplia gama, que incluye memoQ, Memsource y DéjàVu.

Suba su XLIFF traducido y obtendrá un PDF en formato completo. Cualquier edición posterior se puede hacer GRATIS usando Infix 7, que permite la edición de documentos PDF con funciones avanzadas, como la corrección ortográfica, búsqueda y reemplazo, entre otras.
Para obtener más información, visite https://www.iceni.com/transpdf.htm
OFERTAS ESPECIALES, MENSUALES
TRADOS STUDIO Encuentre las ofertas en https://www.traductores.org.ar/beneficios/trados-studio/ o escríbanos a trados@transeconomy.com o a beneficiostecnologicos@traductores.org.ar y le enviaremos la cotización correspondiente al precio del día.
Para solicitar información y el código de descuento para la compra, envíe un correo electrónico a beneficiostecnologicos@traductores.org.ar

+
Accedé desde el «Panel de matriculados»